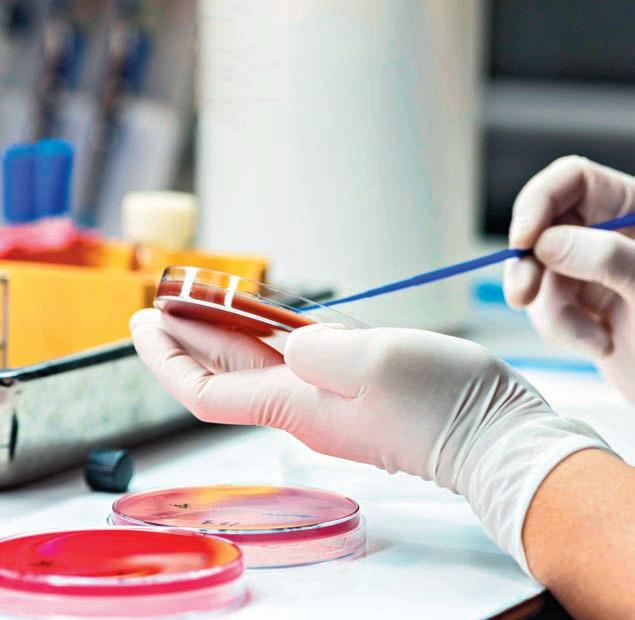

During this year’s contract negotiations, nurses and health-care professionals took to the streets to demand better staffing, working conditions, and compensation, improvements aimed at increasing the number of nurses to achieve better patient care. Those talks broke down without an agreement. There’s a direct line between this situation and the Ford government, which has been underfunding health care and undervaluing nurses for years. It’s like Ford wants the public system to fail.
Nurses are highly valued in other jurisdictions for their skills and education. But in Ontario, Doug Ford suppressed nurses’ wages and suspended their right to fair bargaining, actions that made the nursing shortage worse. Employers and the government need to prove - right now - that nurses are valued here, too. Because the clock is ticking.









As usual, Canada’s provincial premiers have been demanding the federal government give them tens of billions more per year than they’ve just been offered for health care, while at the same time claiming (incorrectly) that health care is solely their jurisdiction.
But if health care is solely a provincial responsibility, with taxing powers of their own, why do they demand massive federal cash transfers with no strings attached? There are several possible reasons.
One is that health care costs are increasing too rapidly. This is not a new argument. In 1977, the federal government cut federal income taxes, giving “tax room” for the provinces to raise theirs by equal amounts, leaving overall taxes for Canadians the same, while shifting billions of dollars of revenue from federal to provincial treasuries – the infamous “tax point transfer.” The provinces could thereby fund more of their health care from revenues growing in line with the economy.
But the provinces conveniently ignore this major reform and count only federal transfers in cash – then blame the federal government for being stingy, while avoiding raising their own taxes.
Of course, the federal government does have a national role in health care and needs to be accountable to Canadians – so why shouldn’t they attach strings to any additional cash transfers to the provinces, ensuring the funds are being used to improve health care and Canadians’ health?
MAY 2023 ISSUE
EDITORIAL: April 6
ADVERTISING:
Display – April 21 | Material – April 25
Monthly Focus:
Surgical Procedures/Pain Management/
Palliative Care/Oncology: Non-invasive surgery, plastic surgery, orthopedic surgery and new surgical techniques including organ donation and transplantation procedures. New approaches to pain management and palliative care delivery. Approaches to cancer diagnosis and treatment.
+ NATIONAL NURSING WEEK SUPPLEMENT
Another reason provinces say they need more money is that health care is so expensive. However, Canadians do not know whether the provinces are managing health care cost-effectively. Indeed, evidence suggests not.
Internationally, Canada spends more per capita on health care than many other OECD countries, but performs poorly.
There are also worries about an aging population. But many OECD countries both spend less on health care per capita than Canada, and already have more elderly populations.
So, the real solution is not throwing more federal money to the provinces. Rather, it is overcoming decades-long blockages preventing meaningful health care reforms to contain costs and improve outcomes.
Broadly speaking, there are four main areas of health care: hospitals, drugs, doctors and long-term care. Longterm care has been seriously underfunded for decades, so the federal proposal to increase pay for personal support workers is most welcome.
But within long-term care, there is a huge imbalance between home care and nursing homes.
Provinces seem keen to build new nursing homes, while continuing to starve home care of funding. This is not what Canadians want or need, nor is it cost effective.
Other than for long term care, there is no need for health care costs to rise dramatically over the coming decades – if there are appropriate structural reforms and better more integrated management.
Continued on page 6
EDITORIAL: May 11
ADVERTISING:
Display – May 26 | Material – May 30
Monthly Focus:
Precision Medicine/Volunteers and Fundraising/ Pharmacy and Medication Management: Developments in the field of personalized medicine. Innovative approaches to fundraising and the role of volunteers in healthcare. An examination of safe and effective use of medications in hospitals including medication management.
+ ANNUAL HOSPITAL PHARMACISTS’ ASSOCIATION SUPPLEMENT + SPECIAL FOCUS: CANNABIS
THANKS TO OUR ADVERTISERS Hospital News is provided at no cost in hospitals. When you visit our advertisers, please mention you saw their ads in Hospital News.
610 Applewood Crescent, Suite 401 Vaughan Ontario L4K 0E3 TEL. 905.532.2600|FAX 1.888.546.6189 www.hospitalnews.com
Editor Kristie Jones editor@hospitalnews.com
Advertising Representatives
Denise Hodgson denise@hospitalnews.com
Publisher Stefan Dreesen stefan@hospitalnews.com
Accounting Inquiries
accountingteam@mediaclassified.ca Circulation Inquiries info@hospitalnews.com
Director of Print Media

Lauren Reid-Sachs Senior Graphic Designer Johannah Lorenzo
Barb Mildon, RN, PHD, CHE
VP Professional Practice & Research & CNE, Ontario Shores Centre for Mental Health Sciences
Helen Reilly, Publicist Health-Care Communications
Bobbi Greenberg, Health care communications
Sarah Quadri Magnotta, Health care communications
Dr. Cory Ross, B.A., MS.C., DC, CSM (OXON), MBA, CHE Vice President, Academic George Brown College, Toronto, ON
ASSOCIATE PARTNERS:
Hospital News is published for hospital health-care professionals, patients, visitors and students. It is available free of charge from distribution racks in hospitals in Ontario. Bulk subscriptions are available for hospitals outside Ontario.
The statements, opinions and viewpoints made or expressed by the writers do not necessarily represent the opinions and views of Hospital News, or the publishers.
Hospital News and Members of the Advisory Board assume no responsibility or liability for claims, statements, opinions or views, written or reported by its contributing writers, including product or service information that is advertised.
Changes of address, notices, subscriptions orders and undeliverable address notifications. Subscription rate in Canada for single copies is $29.40 per year. Send enquiries to: subscriptions@ hospitalnews.com
Canadian Publications mail sales product agreement number 42578518.
When 66-year-old Jeff Pitman from London, Ontario, experienced an aortic dissection and aneurysm compromising blood flow to his legs and kidneys, a team of vascular surgeons at London Health Sciences Centre (LHSC) were the first in North America to use the Artivion E-nsideTM aortic stent-graft to save his life.
As an organization that strives to find innovative solutions to improving patient-centered care, LHSC’s Dr. John Landau and Dr. Luc Dubois recently received approval through Health Canada’s physician-request special access program to use a device currently only approved for use in Europe. Overall, recovery time was reduced to a matter of weeks, from what would typically be about six months with a more traditional aortic surgery. With Health Canada’s approval, and the availability of the device through ATES Medical, Artivion’s Canadian distributor, this life-saving procedure was made possible.

“The successful use of the E-nsideTM device will help pave the way for additional use at LHSC and at other centres across Canada,” said Dr. John Landau, a vascular surgeon at LHSC, and member of the team who performed the procedure. “Typically, aortic dissection would be a challenging procedure to treat and often the only option is traditional open surgery requiring invasive surgical access through the chest and abdomen. A regular surgery would have required significantly

more recovery than Jeff experienced. In a matter of three weeks, he was back to normal. This would not have been possible with the equivalent open operation.”
Starting in October 2022, Pitman underwent three advanced, minimally-invasive procedures to install the E-nsideTM aortic stent-graft.
“I am very grateful to Dr. Dubois and Dr. Landau for identifying this innovative option given the severity of my condition,” said Jeff Pitman. “Not only did this device and procedure save my life, but I had a remarkable recovery considering I had three surgeries over the course of a month. I was able to be back home with my family much sooner than I ever expected.”
The Artivion E-nsideTM device allowed Drs. Landau and Dubois to perform the surgery through minimal entry points, using approximately four-centimeter incisions in the arm and groin. These types of minimally invasive procedures are often safer, and result in a better experience for the patient including reduced pain, fewer complications and a quicker recovery, requiring less time in the hospital.
“By using an off-the-shelf endovascular stent-graft the emergency procedure could be performed much sooner,” said Dr. Luc Dubois, a vascular surgeon at LHSC and member of the team who performed the surgery. “We sometimes perform advanced
endovascular aortic surgery with a custom device that is tailor-made to the patient’s anatomy; however, in this case we needed an urgent solution given the patient’s life-threatening condition. With the E-nsideTM stent-graft, we were able to choose a ready-made device that best suited the patient’s anatomy and expedite a minimally-invasive procedure much more quickly than usual, and with much less risk.”
The E-nsideTM aortic stent-graft is a device that allows LHSC to use minimally invasive endovascular techniques to treat aortic dissection and aneurysm without compromising blood flow to other major abdominal organs. While there are other devices that exist on the market, they are often custom-made and tailored to the patient’s anatomy, taking more time to make and requiring more intensive surgical installations. The advantage of the E-nsideTM stent-graft is that it has a unique design with branches that are nested inside the device, allowing it to be used in a wide range of people with varying anatomies.
In this specific scenario, the E-nsideTM stent-graft was the only device LHSC’s surgical team could safely use given the complex nature of Pitman’s aortic condition. The installation of this device not only repaired Pitman’s aorta but it also significantly reduced his recovery time and any complications, getting him home and back to his regular activities much sooner.
Continued on page 6

Continued from page 5
While this was the first time LHSC has used the Artivion E-nsideTM stent-graft, the hospital performs approximately 20 advanced aortic procedures like this each year. Given the successful use of this device and
Pitman’s remarkable recovery, LHSC plans to continue to apply for special approval from Health Canada to use E-nsideTM stent-graft again in the future, should a patient’s condition warrant it. n H
Even though paediatric emergency department (ED) visits decreased overall during the COVID-19 pandemic, a newly published study co-authored by Dr. Daphne Korczak at The Hospital for Sick Children (SickKids) and led by Dr. Sheri Madigan at the University of Calgary shows there was a sharp increase in emergency department visits for attempted suicide and suicide ideation among children and adolescents during that same period of time.
The study, published Mar. 9, 2023, in Lancet Psychiatry, provides a meta-analysis of 42 studies representing over 11 million paediatric ED visits across 18 countries, and compares data on ED visits prior to the pandemic with those that took place during the pandemic up to July 2021.
Continued from page 4
Of course, “you cannot manage what you can’t measure.” Canada generally lacks data to understand one of the most important signals of inefficiency –“postal code medicine,” the often large variations across regions in numbers of surgeries and other kinds of health care, but these are inputs, not outcomes.
Data to provide explanations why c-section rates and stenting after heart attacks can vary threefold across health regions are generally lacking. In the rare cases where we have the data, there are health regions with no obvious benefit in terms of health outcomes – hence wasting money.

So why do provinces continue to fund health care that has no benefits in terms of peoples’ health? This may take the form of inappropriate diagnostic imaging, unnecessary lab tests, repetitive doctor visits, overly expensive “me too” prescription drugs, excessive invasive surgeries, and doctors providing services more than adequately provided by less costly nurse practitioners in primary care teams.
And why do hospitals have so many beds occupied by patients who could be more appropriately and less expensively cared for by long-term care?
One reason is that too many Canadians are overly wowed by new drugs and diagnostics. Putting public monies into home care and collecting and analyzing the data needed for cost-effective management of health care is not as sexy.
Let’s also “follow the money.”
Overall doctors may see their own incomes fall if funding were to be redirected to primary care teams. Hospital budgets would fall if some of their funding were reallocated to long-terms care. Pharmaceutical firms would see declining profits if a national pharmacare program were implemented.
Before more is spent on health care, Canadians need to insist on evidence that they are getting better value for the existing expenditures, and demand their politicians exercise the leadership to implement needed structural reforms. n H
The numbers show that while there was a 32 per cent reduction in pediatric ED visits for any health-related reasons during the pandemic, there was an alarming 22 per cent increase in the number of children and adolescents going to EDs for suicide attempts, and an eight per cent increase in visits for suicide ideation.
“It has been incredibly challenging for researchers to both derive and interpret the data in real-time during the COVID-19 pandemic to disentangle the impact on the mental health of children and adolescents,” says Korczak, Child and Adolescent Psychiatrist and Associate Scientist in the Neurosciences & Mental Health program at SickKids. “This work extends our scientific understanding of how young people fared during the pandemic and indicates we need to pay attention to how our children and youth are feeling and functioning today.”
The researchers included studies published between Jan. 1, 2020, and Dec. 19, 2022, that contained data on paediatric ED visits before and during the COVID-19 pandemic up to the summer of 2021. In addition to showing an overall increase of ED visits related to suicide attempts and ideation, the researchers found this change was larger for girls (39 per cent increase)
than boys (6 per cent increase). Rates of self-harm also increased substantially among adolescents (18 per cent increase) and decreased among children who were 12 years old and younger by 15 per cent.
While the study shows that rates of ED visits for other mental health concerns, such as anxiety, declined by 19 per cent, the researchers say this finding should be interpreted in the context of an overall 32 per cent decrease of paediatric ED visits for any health concerns during the pandemic. Furthermore, previous data show that calls to crisis hotlines and use of community-based mental health supports increased during the pandemic, suggesting that children and youth experiencing less acute forms of mental distress may have used resources outside of the ED.
At SickKids, Korczak has been leading a group of four research teams examining the pandemic’s impacts on the mental health of children and youth in Ontario. Her previous work has shown that social isolation and a loss of in-person school had a significant impact on mental health and found a strong association between time spent online learning and depression, inattention, irritability and anxiety in school-age children.
“During the pandemic, children and youth experienced a multitude of stressors and had to try and manage these without the help of the support systems that they would have otherwise relied on, like seeing friends, school and extra-curriculars. This study underscores the extent to which children and youth have been struggling and pushed beyond their ability to cope, leading to more ED visits for suicide attempts and ideation,” says Korczak, who is also an Associate Professor in the Department of Psychiatry at the University of Toronto. “Our findings tell us that we need to focus our efforts on providing children with the elements that we know underpin good mental health and integrate mental health supports within our community, education and healthcare systems. n H
Why are Canadians having problems accessing physicians despite historic highs in physician numbers? Factoring in changing demographics and physician work trends can help with physician workforce planning, according to a new analysis in CMAJ (Canadian Medical Association Journal).
“[T]he increasing [health care] needs of an aging population have been empirically important since around 2005, while the supply of physician service hours has simultaneously declined in a manner that is largely unrelated to the evolving age–sex composition of the physician workforce,” writes Dr. Arthur Sweetman, Department of Economics, McMaster University, Hamilton, Ontario, with coauthors. “Thus, relying on simple trends in physicians-per-capita ratios for workforce planning is misleading and not helpful.”
The authors hope their analysis will inform governments and the medical profession in planning the appropriate number of new physicians who should enter medical practice.
The analysis looked at trends in the number of physicians and hours of work, and factored in the needs of an aging population between 1987 and 2020. Physician hours of work, while being higher than in most other occupations, declined by 20.6 per cent, from an average of 54.3 hours per week in 1987 to 43.1 hours per week in 2020.
“Despite working more than other occupations, physicians have faced mounting challenges meeting patient needs,” says coauthor Dr. Boris Kralj, a professor of economics at McMaster University. “The 1980s physician workload proved unsustainable. In 1987, the average physician worked almost 13 and a half hours per week more than the average Canadian worker, whereas in 2020 that gap had declined to about 6.2 additional hours per week.”
Simple adjustments for population aging and physicians’ declining hours of
work change the apparent 35 per cent increase in physicians per capita between 1987 and 2019 into a 4 per cent reduction.
“The current physician practice environment is not one of resource abundance as suggested by high physician counts, but rather a period of physician shortages like that in the late 1990s. In fact, we are below levels observed in 1987,” says Dr. Kralj. “The majority of the increase in physician supply over the past 3 decades has been offset by the rising needs of an aging population.”
The analysis also debunks the theory that larger numbers of physicians who identify as working fewer average hours is a substantial contributor to the shortages.
“Females had lower average hours, but that average was relatively stable from 1987 to 2020,” write the authors. “In contrast, the hours of male physicians declined, and the gender gap in hours diminished across the period.”
They suggest several potential reasons for the decline in working hours beyond the modest contribution from a larger proportion of older and female
physicians in the workforce. Other often-discussed issues, such as physician burnout combined with a desire for an improved work–nonwork balance, must also be at play.
“Our analysis shows that measures of physicians per capita need to be complemented with both demandand supply-side adjustments to inform planning for health human resources in medicine.”
The authors suggest caution in interpreting 2020 numbers as that was the start of the COVID-19 pandemic, and they were unable to evaluate trends for the later part of the pandemic owing to data limitations.
“Physician workforce planning in Canada: the importance of accounting for population aging and changing physician hours of work” was published March 6, 2023. n H
Gestational diabetes has been reported to be on the rise, but a new study from British Columbia found that changes in screening practices explain much of the increase. The study is published in CMAJ (Canadian Medical Association Journal).
In Canada, the rate of gestational diabetes increased from four per cent of deliveries in 2004 to seven per cent in 2014 across all racial and ethnic groups. The rise has been speculated to be because of older maternal age, less exercise and poor diet, but the reasons for the increase are poorly understood.
Researchers looked at data on more than 550 000 pregnancies in BC from 2005 to 2019 as well as the screening method and rates of screening completion. During the study period, diagnoses of gestational diabetes doubled, from 7.2 per cent to 14.7 per cent.
The authors found the increase was largely due to changes in gesta-
tional diabetes screening practices, from a two-step screening process to a more sensitive 1-step screening process. When they adjusted for the increase in screen completion, changes in screening methods and population factors, diagnoses of gestational diabetes increased by less than one-quarter across the 15-year study period.
“Despite concerns that a higher proportion of pregnant people with high BMIs, older maternal age or obstetric risk factors were leading to higher rates of gestational diabetes, these were not important contributors to the yearly increase in gestational diabetes in BC,” says Dr. Elizabeth Nethery, School of Population and Public Health, University of British Columbia, with coauthors.
A diagnosis of gestational diabetes affects both the patient and the health system, requiring lifestyle changes, additional health care appointments and
monitoring during and after pregnancy. In 2017, BC had the highest provincial rate of gestational diabetes at 13.9 per cent, compared with nine per cent across Canada.
“[O]ur study highlights the importance of having data on screening methods and completion to better understand the rising incidence of gestational diabetes observed elsewhere,” the authors conclude.
“We need to look at gestational diabetes policies in BC, because screening changes alone are driving the substantial increase in diagnosis in our province. We need to make sure that any increase in diagnosis is truly beneficial to both patients and the health care system,” says Dr. Nethery, lead author of the study.
“The effect of changing screening practices and demographics on the incidence of gestational diabetes in British Columbia, 2005–2019” was published March 20, 2023. n H
Increase in gestational diabetes rates linked largely to screening
“DESPITE WORKING MORE THAN OTHER OCCUPATIONS, PHYSICIANS HAVE FACED MOUNTING CHALLENGES MEETING PATIENT NEEDS.”
Every day, hundreds of thousands of Canadians access healthcare services. Many undergo critical life-saving procedures, while others receive important routine and follow-up care. With their incredible training and practice, clinical and professional healthcare teams play the leading role in delivering compassionate, effective and safe care to Canadians. Next to this everyday excellence, the reality is that many children, adults and seniors across Canada wait too long to access the care and treatments they need. If waiting wasn’t hard enough, the stark truth is that 5-million Canadians don’t have access to a family doctor or primary care team – a critical node to wellness.
Long wait times to access care or services for clinical procedures is a known contributor to reduced functional and physical wellness for Canadians diagnosed with one or more health conditions. Declining health while waiting increases healthcare utilization and costs, making it even more challenging on the person and care interactions. Many lose the race. In 2021−22, 13,581 patients across Canada died while on waitlists for surgical, diagnostic, or clinical procedures.
Value-based healthcare (VBHC) is a systems approach to healthcare delivery, management and coordination, currently embraced by many of the world’s most advanced healthcare systems. It represents a shift away from volume-based (fee-for-service) funding models towards outcomes-based funding delivered by a patient-centric care model. This model features integrated and inter-professional healthcare teams serving the needs of a person along their care journey.
What’s unique about VBHC is how the model systematically measures and
honours outcomes that matter to patients and as a result improves shared decision-making. It also includes a transparency to the costs of care, supporting sustainable operations and informing the effectiveness of current and new evidence-based treatments, technologies, and service innovations.

Evidence shows that considerable numbers of healthcare providers underestimate (or even dismiss) pain and suffering that patients experience. Symptom underestimation in cancer, specifically, has been associated with inadequate pain control from advanced treatment regimens, poor quality of life, poor compliance with treatment recommendations, and reduced survival.
Patient Reported Outcomes (PROs) are defined as “changes in health that
result from specific health care investments or interventions.” Facilitated by structured survey tools and ‘experience dialogues’, PROs can be completed by patients themselves or by caregivers, clinicians or social care professionals supporting a patient’s circle of care.
Systematic collection and use of PROs in routine practice can help ensure that symptoms are identified, acknowledged, and addressed in a timely fashion. The benefits include improved patient–provider communication, better symptom management and quality of life, higher patient satisfaction; and in cancer care – overall survival.
Hospitals and care organizations across Canada, including the Jewish General Hospital in Montreal; and St. Paul’s Hospital, in Vancouver –among others, have demonstrated that it is feasible to integrate PROs into routine care. If integrated with hospital and patient information systems,
automated alerts based on patient or caregiver completed surveys can trigger timely care management pathways and reduce emergency visits – catching potential acute events before they happen. So why aren’t the integration of PROs to patient care and system management routine practice?
In the most recent report from The Conference Board of Canada’s Value-Based Healthcare Canada research centre looking at PROs in colorectal cancer treatment, highlights the value of their use with specifics to guide organizations on standardizing the routine collection of PROs. These range from data management, information system interoperability and advanced analytics. When we hear reports that provinces don’t want to share outcomes data in support of new federal transfer agreements, the question it begs is: why not? A 2022 survey of over 2,000 Canadians showed 82 per cent are willing to share their health information to support improving the performance of the health system; and strategies to improve their own health or advance scientific research. It’s clear that Canadians are open to participating in meaningful efforts to contribute to reporting outcomes that matter to them to improve health system performance, management, research and discovery.
With growing pressure to ensure the sustainability and resiliency of Canada’s healthcare systems and supply chains, VBHC approaches across Canada are gaining momentum. Yet, broad system transformation and monitoring of progress is needed to truly realize improved access to care and the best health and wellness outcomes for patients, families, and health professionals alike.
The economic and social imperative for increasing the value and accountability of federal, provincial, and yes –private healthcare investments – that will together sustain Canada’s health ecosystem has never been more important. The survivability of Canada’s health systems rests on it. The fact is, different is necessary. n H
IN 2021−22, 13,581 PATIENTS ACROSS CANADA DIED WHILE ON WAITLISTS FOR SURGICAL, DIAGNOSTIC, OR CLINICAL PROCEDURES.
This year, 100,000 Canadians will be diagnosed with heart failure. If you’re one of the 750,000 people already living with heart failure, you know how worrying it can be for you and your family and caregivers. The shortness of breath, even when lying down. The weakness and fatigue. The inability to carry out simple activities such as walking or climbing stairs.
Access to medical facilities and cardiac specialists who can provide expert care is critical. While living in a big city may provide some people access to specialized care, it isn’t necessarily accessible to everyone who needs it when they need it. Access can also be challenging for people living in smaller communities, where it may not be readily available.
Boehringer Ingelheim (Canada) Ltd. (Boehringer Ingelheim Canada) is honoured to partner with the digital innovators at University Health Network (UHN), a world leader in heart failure care, who have developed research-based solutions that address the inequalities in access to care and deliver the benefits of specialized heart failure management at home, at any time, wherever home may be.
Medly is a remote management program that uses technology to address challenges in caring for people with complex health issues. Developed at UHN by an interdisciplinary team of clinicians, researchers and engineers, it transforms the way clinicians and patients manage heart failure and improve the experiences and outcomes for patients. In operation since 2016, it is already having significant positive impact on patients in and around Toronto and some remote northern communities. Now it’s time to support scaling it up to benefit heart failure patients and their families across Ontario.
It’s estimated that heart failure touches the lives of one in three Canadians, either because they have the disease or because it affects a
family member or close friend. Heart failure is also one of the leading reasons people are admitted – and readmitted – to hospital, costing Ontario hospitals nearly a quarter of a billion dollars annually. According to the Heart and Stroke Foundation of Canada, the annual healthcare costs associated with heart failure in Canada could reach $2.8 billion by 2030.
In looking at these numbers, we know how necessary innovations like Medly are: for patients, for care providers, and for our health system overall. Our health systems are also under enormous non-financial pressure: from COVID-19 backlogs, surges in respiratory illness, and with burn-out among healthcare workers. We have a duty, as members of the health sector and health system, to provide options that can ease this pressure.
Public-private partnerships like the one between Boehringer Ingelheim Canada and UHN allow for innovation in patient care, without sacrificing quality. In the case of Medly, our partnership is helping to expand access to a tool that improves the care patients receive while also improving professional satisfaction for the care providers that use it.
The Medly Program provides more patients with care while keeping as many as possible out of hospital. It has a proven track record backed by peerreviewed research, which shows it cut the number of heart-failure related hospitalizations by 50 per cent and reduced hospitalizations from all causes by 24 per cent. The Medly Program uses a high clinician-to-patient ratio (one Medly nurse can support up to 250 patients), and its streamlined data
systems mean lower costs, lower stress, and better outcomes.
With healthcare budgets and hospital staff under increased strain, we need public-private partnerships to support and help fund innovative healthcare solutions. UHN is already a world leader in care, education, and research. By working together with Boehringer Ingelheim Canada, an innovative healthcare solutions partner that supports public healthcare objectives for heart failure care and beyond, UHN is able to expand access to Medly and enable healthcare teams to better support as many patients as possible.
The Boehringer Ingelheim CanadaUHN partnership reduces risk for the public healthcare sector by absorbing costs and testing success. It includes financial and in-kind resources and medical expertise from both the public and private sectors to create sustainable and transformative healthcare solutions. The pragmatic and collaborative mindset of our partnership supports strategies tailored to meet local healthcare needs, deliver solutions designed to advance clinical priorities and enhance patient care.
Access to Medly is a lifeline to heart failure expertise and ongoing management, particularly for patients who don’t have access to a cardiologist or family physician. Our combined goal now is to scale up the use of Medly as a digital therapeutic to deliver equitable access to quality heart failure care in communities across Ontario and throughout Canada.
At Boehringer Ingelheim Canada, we’re committed to identifying and deploying innovative technologies and health system processes in public healthcare. By leveraging digital healthcare solutions, and through public-private partnerships like the one with UHN, we can increase access to care for all patients no matter where they live and help address health inequities by bridging healthcare gaps. n H

MEDLY IS A REMOTE MANAGEMENT PROGRAM THAT USES TECHNOLOGY TO ADDRESS CHALLENGES IN CARING FOR PEOPLE WITH COMPLEX HEALTH ISSUES.
The recipe for a healthy lifestyle is to eat well, stay active, reduce stress and take medication as prescribed. For someone with type 2 diabetes, small changes in any of those categories can have big impacts – positive or negative. Living with diabetes requires ongoing access to diabetes care to help manage the condition, so patients meet with their health care team about once every three months. But what if they’re having trouble between appointments?
Hamilton Health Sciences (HHS) researcher Diana Sherifali set out to
discover if it’s possible to prevent a small issue from becoming a bigger one by using artificial intelligence. She’s taking the first steps to develop a health coaching algorithm to help people with diabetes. This algorithm could be added to existing fitness or wellness apps that already track diet and exercise.
As a clinical nurse specialist at HHS, an associate professor in McMaster University’s School of Nursing and associate scientist at the Population Health Research Institute (PHRI), Sherifali has
been exploring if a type of artificial intelligence called machine learning could be the solution. PHRI is a joint institute of HHS and McMaster University.
“Individuals living with diabetes are managing the condition every day. This means at least 95 per cent of diabetes management occurs outside of the health-care system,” says Sherifali, who is also a certified diabetes educa-
tor who understands the benefits of health coaching. “It’s unrealistic for their care teams to be helping them on a daily basis. But, if a machine learning algorithm is developed and applied to existing technology that these individuals already use, it could fill in some of the support needed between appointments.”
Type 2 diabetes occurs when your pancreas doesn’t make enough insulin, which regulates sugar within the body, or your body doesn’t respond well to insulin. There is no cure, so it requires managing blood sugar levels. This is done through dietary modifica-

tions, exercise, maintaining a healthy body weight, monitoring blood sugar levels and possible medication or insulin injections.
If the health coaching algorithm is applied to a wellness tracker it can use the existing diet and exercise data. Then, once individuals add their weight, blood sugar levels and medications, the algorithm can determine if changes need to be made and provide recommendations on what to do.





To explore and develop this idea further, Sherifali partnered with experts in digital health and data science at HHS’ CentRE for dAta Science and digiTal hEalth (CREATE).
“With my basic knowledge of artificial intelligence I knew I needed to work with CREATE, so I approached them with the idea right from the start,”
says Sherifali. “I was excited when I was told it was worth exploring.”
When you play chess on your phone do you ever wonder how the computer knows how to play? By automatically playing thousands of games and being rewarded for victories and penalized for losses, a computer can eventually learn winning strategies for nearly any situation. This approach to machine learning is called reinforcement learning and is leading to cutting-edge advancements in many applications of artificial intelligence, including self-driving cars.
The same approach has been used by CREATE for computerized diabetes health coaching, says Jeremy Petch, CREATE’s founding director.



“We provide the algorithm with health data, a medical professional’s recommendations and the outcomes – good and bad,” says Petch. “This allows it to learn the best strategy under all different circumstances, just like the computer opponents you play against on your phone.”
In this case, the data includes blood sugar levels, medications, nutrition, physical activity, weight and stress.
After developing and testing the algorithm, the team determined that it does provide accurate initial recommendations.
“Now that we’ve determined the algorithm can learn the appropriate recommendations for common issues encountered by those with type 2 di-
abetes, we need more detailed data to continue to refine it,” says Petch.
The next stage of the study will teach the algorithm how to provide accurate recommendations with more complex data. Then it will eventually be tested with clinicians and finally, patients.
“The challenge is that there’s always more data,” says Sherifali. “The algorithm isn’t meant to replace in-person appointments so we’ll need to determine at what stage there is enough data for the algorithm to be effective with coaching individuals through many different issues, while leaving complex scenarios for a medical team to address.”
Since fitness and wellness apps are already well established as a vehicle to house and track the kind of data that people with type 2 diabetes are already monitoring, the implementation of the algorithm into these apps won’t be the most challenging part of the project. The first steps – determining if the algorithm will work, are actually the hardest steps.
So Sherifali says she’s excited that this first stage is already showing success. It means that heath coaching for those with type 2 diabetes could be at their fingertips in the near future. n H
“INDIVIDUALS LIVING WITH DIABETES ARE MANAGING THE CONDITION EVERY DAY. THIS MEANS AT LEAST 95 PER CENT OF DIABETES MANAGEMENT OCCURS OUTSIDE OF THE HEALTH-CARE SYSTEM.”
epsis is a leading cause of death worldwide,” says Jacqueline Fortier, Manager, Evidence Synthesis Unit at the Canadian Medical Protective Association (CMPA). “But diagnosing sepsis can be challenging, and this can lead to delays in treatment. This is what motivated CMPA’s new research paper.”
“We want to provide healthcare providers with practical tips for catching sepsis early on,” adds Fortier.
That new CMPA research paper – Diagnostic delays in sepsis: Lessons learned from a retrospective study of Canadian medico-legal claims, now available in the latest edition of Critical Care Explorations – highlights the diagnostic challenges of sepsis and offers advice to physicians, about the importance of communication and collaboration to curb delays in diagnosis.
Sepsis occurs when the body’s severe response to infection results in organ dysfunction. In Canada alone, there are approximately 75,000 cases each year, resulting in over 16,000 deaths. Not every infection leads to sepsis, so it can be difficult to connect a patient’s early non-specific symptoms, such as fever, discomfort, and elevated heart rate, to an eventual progression towards sepsis. Delayed diagnoses can result in poorer outcomes and higher mortality rates.
The CMPA study focused on medico-legal cases (including regulatory College or hospital complaints and civil legal actions) resolved between 2011 and 2020. In general, the CMPA’s data reflects only the very small portion of cases where the complainant (e.g. a patient, healthcare professional, etc.) believes that the physician did not meet the standard of care. The CMPA’s goal is to analyze what went wrong, and use this knowledge to provide information to improve patient safety overall. Researchers identified 1,075 cases related to sepsis or relevant infections, of which 163 (15.2%)
included peer expert criticism of the diagnostic process. Cases occurred in all types of care settings including family physicians’ offices, walk-in clinics, hospitals, and emergency departments, and most of the physicians involved were specialists in family medicine, emergency medicine, or surgery.
A significant takeaway from these findings is the importance of clear communication between providers. In some cases, the physician may not have been notified about a patient’s
deteriorating vital signs, or the physician may not have provided enough detail for nurses to understand what to do if the patient’s condition worsened. Working as a team to establish a culture of collaboration and collective situational awareness can mitigate these potential issues.
Communication with patients and their family members is also a key factor in addressing diagnostic delays in sepsis. Sepsis is an evolving process, and it can be difficult to determine when common infections like pneumonia, influenza, or streptococcus could become more serious and lead to sepsis.
“Physicians should ensure that the patient recognizes new or progress-
ing symptoms,” says Dr. Gary Garber, Director of Safe Medical Care Research, CMPA. “When you send a patient home, make sure they know what constitutes a progressive symptom, and under what circumstances they should return for another assessment.”
The CMPA study also suggests that repeat visits to care providers may represent an early warning sign of sepsis. Nearly half of the patients in this analysis made multiple visits to their family physician, a walk-in clinic, or the emergency department in the leadup to the development and diagnosis of sepsis. Some made as many as five visits. When a patient has sought care repeatedly, vigilance may be required in the re-assessment.
Peer reviewed research is conducted using CMPA data, the largest collection of physician medico-legal data in the world. The CMPA’s peer-reviewed research informs the development of evidence-based products and services to enhance the safety of patient care and reduce the risk of harmful events.
The CMPA website features published research and useful learning resources to assist physicians in improving patient safety, including Good Practices and eLearning modules. The CMPA also provides member physicians with medico-legal advice and assistance and compensates patients on behalf of members when its proven the patient has been injured as a result of negligent medical care (fault in Quebec).
“This sepsis analysis provides an opportunity to highlight areas where physicians and other healthcare providers can focus efforts for improvement,” says Garber. “We’re currently developing new resources based on this sepsis research, to help physicians reduce the risk of delayed recognition of sepsis and improve patient safety.” n H
SEPSIS IS AN EVOLVING PROCESS, AND IT CAN BE DIFFICULT TO DETERMINE WHEN COMMON INFECTIONS LIKE PNEUMONIA, INFLUENZA, OR STREPTOCOCCUS COULD BECOME MORE SERIOUS AND LEAD TO SEPSIS.
•New hire not covered by a group health plan?


•Have health coverage through a spouse but don’t have long term disability coverage?
• Losing employee benefits? Retiring or transferring from a full time position?
In response to the pandemic, health systems across Canada quickly pivoted their delivery of care and launched or expanded virtual care options. Since then, health systems are recognizing how virtual care can address the diverse needs of patients and health care providers to deliver safe, timely and equitable care.
In 2020–2021, the Government of Canada provided funding to the provinces and territories to enhance technology and infrastructure that would facilitate the delivery of virtual care, to evaluate the impacts of virtual care or to establish policy supports for virtual care. As a result, provinces and territories implemented a wide range of initiatives.
To share the successes and challenges of these initiatives and to inform future virtual care policy and delivery, the Canadian Institute for Health Information (CIHI) conducted interviews across the country.
Despite the diversity in priorities throughout the provinces and territories, four common themes tied to the expansion and enhancement of virtual care services were uncovered:
It remains a key virtual care priority. In some provinces and territories, the strategies focused on ensuring that individuals with different socio-economic means were not disadvantaged. In others, the focus was more structural in nature, for example, ensuring internet access for rural and remote communities, which was a key equity issue for most jurisdictions.
In response to the many people facing barriers to using virtual services such as access to technology and connectivity and digital health literacy, jurisdictions are addressing these issues by:
• Providing locations, such as community health centres, where patients can access the technology to engage in virtual care;
• Developing device-lending programs where patients can obtain the necessary technology for virtual care programming with minimal out-ofpocket costs;
• Providing education and support to both patients and providers on using available virtual care technologies;

• Ensuring that digital access options are accompanied by non-digital options, to meet patients’ needs and circumstances; and
• Providing translation services, and having technology platforms and information materials available in different languages so that patients can access virtual care in their primary language.
High-quality virtual care rests on a foundation of seamless data-sharing to support quality and continuity of care; however, connected care – systems that communicate with each other – is a long-standing system challenge.
Most provinces and territories still have a way to go to achieve standardized data collection, and some are still identifying and defining their specific data needs. In some jurisdictions, certain regions, sectors or providers may still collect data using manual or paper methods or processes, hindering progress. Supporting the transition from paper records to digital systems is viewed as an integral part of health systems’ digital evolution.
Most jurisdictions are focused on connected care within their own province or territory and recognize that a future priority must be expanded to include all of Canada. This is particularly
“VIRTUAL CARE HAS GREATLY INCREASED IN MOST HEALTH SECTORS ACROSS CANADA THROUGHOUT THE PANDEMIC,” SAYS KELLY HOGAN, MANAGER, VIRTUAL CARE INITIATIVE, CIHI. “PATIENTS AND PROVIDERS BOTH REPORTED HIGH LEVELS OF SATISFACTION IN USING IT WHEN IN-PERSON CONTACT HAD TO BE MINIMIZED. NOW WE CAN LOOK TO THE FUTURE AND CONTINUE TO INTEGRATE VIRTUAL AND IN-PERSON CARE IN EVEN BETTER AND SUSTAINABLE WAYS TO MEET THE NEEDS OF CANADIANS AND PROVIDERS ACROSS THE COUNTRY.”
relevant for jurisdictions where there is frequent patient travel for medical care outside their provincial/territori-
al borders, and where virtual services could reduce the need for travel.
Continued on page 17
4 common themes tied to the expansion and enhancement of services across the country
Bringing together leaders from across the healthcare and life sciences sector.
Gain the global perspective you need to reshape your organization.
uoft.me/GEMBA-HLS

 By Celine Zadorsky
By Celine Zadorsky
In a study published in MDPI Journal, a team of researchers at Lawson Health Research Institute have shown that the use of technology may assist in better outcomes for those living with both mental health and physical disorders.
Dr. Cheryl Forchuk, Assistant Scientific Director at Lawson, and her team embarked on a pilot study that used smart home monitoring solutions to assist those living with both a mental health disorder and other health challenges. The purpose of this pilot study was to see if technology could improve overall lifestyle and wellbeing.
“We began our research by using hospital prototype apartments – apartment style care spaces within hospital settings – that were equipped with smart home technology solutions such as a screen device, activity trackers, weigh scales and medication dispensers,” says Dr. Forchuk who is also the Beryl and Richard Ivey Research Chair in Aging, Mental Health, Rehabilitation and Recovery at St. Joseph’s Health care London. “Once we tested it in a hospital setting, we wanted to find a way to take this idea out into the community in different kinds of housing and living situations to see if it would be beneficial.”

The research team partnered with the Canadian Mental Health Association (CMHA) and the London and Middlesex Community Housing (LMCH) to work together to retrofit the homes of the 13 study participants.
“We worked together with the participants and their care providers to choose what combination of technology they felt would be best for them,” says Dr. Forchuk. “No matter their health condition each participant wanted to be more active and independent, with the goal of staying out of hospital.”
All smart devices were connected to the Lawson Integrated Database, which is a database that can securely collect data from multiple sources such as health devices. This allowed care providers to send reminders to participants, while also tracking usage and results.
“The key benefits we noted was that study participants started to live healthier lives,” says Jonathan Serrato, Lawson Research Associate. “Participants logged going for walks and exercising more often, as well as making healthier food choices. Those who used the medication dispensers did not miss a single dose. The touch screen devices also allowed participants to
easily communicate with care providers and support networks, and access more resources.”
Following the pilot study, the research team also published a subsequent paper, as a ‘how-to guide’ for utilizing smart home technology interventions as a health care tool.
“This paper is a helpful resource that outlines implications and considerations when it comes to smart home technologies,” adds Serrato. “There are many areas we touch upon such as security, privacy and feasibility as well as hardware and software information for those who would like to take on their own similar type of smart home technology project.”
Lawson Health Research Institute is one of Canada’s top hospital-based
research institutes, tackling the most pressing challenges in health care.
As the research institute of London Health Sciences Centre and St. Joseph’s Health Care London, our innovation happens where care is delivered. Lawson research teams are at the leading-edge of science with the goal of improving health and the delivery of care for patients. Working in partnership with Western University, our researchers are encouraged to pursue their curiosity, collaborate often and share their discoveries widely. Research conducted through Lawson makes a difference in the lives of patients, families and communities around the world. To learn more, visit www.lawsonresearch.ca. n H
The pandemic both exacerbated existing and introduced new challenges with health human resources (HHR). As these challenges impacted the ability to plan, implement and support new virtual care initiatives, jurisdictions have highlighted the importance of having sufficient staff to deliver front-line services and to support policy, governance and strategic work. It is also important to emphasize that the increased uptake of virtual care may have contributed to a challenging HHR environment as health care personnel across sectors were faced with the additional burden of adapting quickly to provide virtual services, such as creating new protocols, changing patient pathways or launching new tools that may not have been well-integrated into existing workflows.
To address HHR challenges, provinces and territories are seeking to provide change management supports, further develop virtual care offerings, expand scopes of practice, and leverage skills and expertise of nurse practitioners and other health professionals to support the delivery of care. Virtual care offers new ways to optimize HHR and can allow a redistribution of available resources by reducing the constraints imposed by provider location. Most jurisdictions are trying to find the optimal balance of in-person and virtual care delivery to meet the needs and preferences of providers, patients and the overall system.
Including both patients and providers in virtual care development and
implementation is a foundation of high-quality, evolving health systems. Most jurisdictions see the importance of including both patient and provider engagement when developing, implementing and evaluating the virtual care policies, strategies and projects they focused on during the pandemic. For example, several jurisdictions launched patient and provider forums and advisory groups to inform their vir-
tual care initiatives. Others conducted surveys and evaluations with providers to support change management initiatives and to improve tool design to meet patient and provider needs.


As provinces and territories consider how virtual care can become an integrated part of their health services beyond the pandemic, data will play a large role. Standardizingvirtual care data, measuring the delivery and impact of virtual care services, and continuing to share information and learn from each other will remain key to improving Canadians’ experience with virtual care.
Please visit www.cihi.ca/en/virtual-care-in-canada for additional information on virtual care services across Canada. n H
Michener’s Fundamentals of Health Care program is specifically designed to help prepare learners of all academic backgrounds for meaningful new positions in health care, and provides foundational knowledge for further post-secondary education.
THE PANDEMIC BOTH EXACERBATED EXISTING AND INTRODUCED
CHALLENGES


The Canadian Anesthesiologists’ Society (CAS) is proud to be celebrating 80 years of being the national specialty society for anesthesiology in Canada. CAS was founded in 1943 as a not-for-profit, voluntary organization and is guided by its vision of transformative patient care, with its mission to serve members and advance the specialty through leadership, advocacy, education, and research. CAS represents 3,000 members (anesthesiologists, GP anesthetists, residents, Anesthesia Assistants, etc.) across Canada and around the world.
Since our inception we have grown from five members and a single committee to an organization with a full board of directors, multiple committees and 14 sections each focused on a particular sub-specialty, practice profile or professional interest. In 1950 we held our first independent Annual Meeting and are excited to now be holding our 73rd Annual Meeting in Quebec City.
In our 80 years we’ve had some incredible milestones. In 1975 we approved the Guidelines for Standards of Practice, the first guidelines by any anesthesia society, which are now revised annually by our Standards Committee. The development of our journal, now called the Canadian Journal of Anesthesia, was first published in 1954 and has been publishing monthly issues since 1995. In 1962 we awarded the Society’s first Gold Medal. This award recognizes a CAS member, ordinarily a Canadian, active or retired, who has made a significant contribution to anesthesia in Canada through teaching, research, professional practice, or administration and leadership. Currently, we have an entire awards program to honour CAS members.
We have created two foundations to support the values of our members. In 1979 we established the Canadian Anesthesia Research Foundation (CARF) to support Canadian research. In 1996 the CAS International Education Foundation (CASIEF) was formed to support the work of volun-

teer anesthesiologists overseas. These practitioners travel to underprivileged countries to work, train and support clinicians in the field of anesthesia to create sustainable training programs. CASIEF currently focuses on collaborative international partnerships in: Nepal, Rwanda, Guyana, Ethiopia, and Burkina Faso.
In 2020 CAS pivoted to launch our first virtual Annual Meeting due to the pandemic and have continued a virtual component in 2022 and 2023. In 2021 we suc cessfully won the bid to host the international World Federation of Societies of Anaesthesiologists (WFSA) conference for Vancouver 2028. This will be the third time CAS will host this event.
As we enter this mile stone, we are committed to continue our mandate of being the voice of the profession and provide a community of learning and collaboration for our membership. This is accomplished through the dedicated efforts of our volunteer committees and sections. Educational opportunities and continuing professional development occurs via resources such as tailored webinars on a wide variety of topics, CPD modules, original research supported through our grants program and the Canadian Journal of Anesthesia.
We are proud to reflect on the last 80 years and are keen to focus on the future and how to improve CAS and best serve the membership. This year, CAS begins a new strategic planning process, taking a 360-degree view with input from board directors, members, partners, and the CAS team. This plan will allow us to assess, prioritize and develop a strong, clear, and measurable map to lead CAS into the coming years. We will build on advocacy efforts and continue to create collabora-
tive relationships with government at the federal, provincial, and territorial levels. We aim to move forward with our issues management work focusing on health human resources and safety concerns, while also increasing our educational offerings for members.
In 1967, CAS initiated the Residents’ Program, later renamed the Residents’ Oral Competition, at the Annual Meeting. To this day, we continue to support the career and development of resident with specialized pro gramming and sessions at the Annual Meeting. In addition, CAS provides all Canadian anesthesia residents free membership to the Society during their five years of residency. Through the CAS Residents’ Section, we support the future of anesthesia, providing opportunities to network, lead and develop a sense of community. The section provides
volunteer opportunities, community and mentorship for the approximately 700 anesthesia residents in Canada.
This year’s CAS Annual Meeting will be held in beautiful Quebec City. We are back to our full, robust and outstanding program, with contributions from 100+ speakers and dozens of engaging sessions. These include Problem Based Learning Discussions (PBLD’s), Test-Enhanced Learning Sessions and Workshops, all featuring leading experts. In addition, the Annual Meeting will host a lively exhibit hall, filled with personal interactions between attendees and exhibitors.
The conference will feature programming from our sections, including Obstetrics, Chronic Pain, Perioperative, Ambulatory, Environmental Sustainability, Pediatrics, Neuroanesthesia, Cardiovascular and Thoracic and more.
The Annual Meeting’s various social events provide an opportunity, to learn, network and celebrate. The conference will also have a select virtual stream for those unable to travel. n H




























































A holistic, comprehensive digital health approach that provides equity of care to meet the needs of all patients, regardless of geographical, cultural, or systemic barriers.
VIRTUES provides access to expert care at home in patients’ community.
VIRTUES has enrolled you into the following Care Path to help improve your health

































































































































VIRTUES is a digital health companion for cardiac patients. It is always there to answer their questions, support them, and offer the best treatment options and access to relevant caregivers.
VIRTUES is a digital health companion for cardiac patients. It is always there to answer their questions, support them, and offer the best treatment options and access to relevant caregivers.

canetinc.ca/digital-health
canetinc.ca/digital-health

Patient engagement is often just an afterthought in profit-driven digital health platforms, where patients are involved only at the end of the development process.
Created by the Cardiovascular Network of Canada (CANet), from the very beginning, VIRTUES was informed and co-designed by patients, for patients, placing it in a league of its own.
The patient-controlled digital health platform utilizes a curated set of modules called Care Paths which are personalized based on the patient’s needs.
Informed by the patient’s medical history, VIRTUES provides treatment recommendations based on Canadian clinical guidelines and notifications at critical points to help manage their condition. These recommendations are sent to the patient’s care team of choice for discussion.

“Our digital health platform utilizes state-of-the-art biosensordriven diagnostics and health informatics—augmented with advanced analytics and wireless connectivity—to provide cardiac patients access to on-demand virtual care,” says Dr. Anthony Tang, CEO and Scientific Director, CANet.
A digital health companion for cardiac patients, VIRTUES helps facilitate better connections with their care teams.
Patients can access VIRTUES anywhere.
In addition to personalized treatment options, patients can access educational resources in the form of videos and infographics, which are also personalized based on their condition and treatment.
VIRTUES also integrates with third-party devices, including those implanted in the heart, to constantly monitor the device status, as well as the health of the patient. The platform sends caregivers notifications, thus offering patients peace of mind.
With VIRTUES at their side, patients can rest assured. They have comfort in knowing they are prepared to tackle unexpected events always.
VIRTUES is not owned by hospitals, businesses, insurance companies, or physicians; it is in the hands of patients.
CANet is a comprehensive network of healthcare professionals, academia, government, industry, not-for-profit, and patients; who perform ground-breaking cardiac research to deliver practical solutions for personal, healthcare, and business applications; while facilitating an equal level of access to care for every patient across Canada.
CANet ensures digital health services are always aligned with evolving patient requirements.


Several CANet patient partners spearhead studies to provide digital health tools and medical content aligned with the unique needs of the patient population. They also take an active part in enhancing the delivery of educational material to patients.
By bringing advanced digital health technologies to the forefront, CANet enables cardiac patients to get the appropriate care they need no matter where they live.
Rather than assuming patient needs, CANet seeks firsthand patient insights and helps them in their care journey by continually researching new approaches of leveraging sensors, voice recognition, cloud computing, and data analytics to facilitate remote diagnoses and disease tracking from the comfort of the patient’s home.
CANet plans to expand the competencies of its network beyond cardiac diseases and enhance healthcare accessibility for patients suffering from other chronic conditions, including diabetes, hypertension, and lipid disorder. CANet aims to help patients manage their diseases, especially when they need to make crucial lifestyle changes.
As patients seek to take control of their health, CANet is helping them do it effectively.
www.canetinc.ca

anada’s first Ministers have finally reached an agreement, not only on Canadian health transfer payments, but just as importantly, on strategies to remedy major failings in Canada’s health sector. These include lack of access to primary care, over-crowded emergency rooms, prohibitive wait-times for surgery, and perhaps the worst record in the OECD for COVID deaths in long term care facilities.
There is another less obvious, but arguably more crucial failing: major shortfalls in collecting, sharing, and making effective use of health data to support health care and public health quality.
Sharing personal health data immediately raises fears about privacy. Yet, when confronted with this question over a year ago, in the context of the pandemic, Canada’s federal privacy commissioner stated, “during a public health crisis, privacy laws still apply, but they are not a barrier to appropriate information sharing.” The inability to share not only data on the genetics of the evolving waves of COVID-19, but also to connect these waves to something as basic as whether an individual had been vaccinated, has imperiled governments’ capacity to control the pandemic.
“Privacy chill” extends well-beyond the pandemic.
How can we understand physician and nurse shortages without data on their training, where they are working or why they are relocating or quitting their jobs? How can we understand if novel “innovations” in health services, such as private for-profit joint replacement facilities, are not luring away publicly financed hospital staff? How can physicians provide competent health services without knowing the health histories of their patients? These essential tasks require robust
and appropriate sharing of personal health data.
These are not new observations. First Ministers’ Health Accords both in 2003/2004 and 2017 included commitments by all jurisdictions to improve health data. These Accords connected health data to “accountability.” But this was not accountability by provinces and territories to the federal government; rather it was to their publics.
Unfortunately, these First Ministers’ commitments have largely failed. Among the reasons are a perception that investing in data takes away from “front line health care,” “short termism” posed by electoral cycles, fears that data sharing and the resulting analyses may reveal embarrassing under-performance, and widespread gaps in health data literacy across the health sector and among the public more generally.
Fortunately, there has been a sea change in attitudes regarding health data since the 2003 and 2017 Health
Accords – many more organizations and members of the public have seen, especially as a result of the pandemic, just how important high quality health data and actionable analysis are.
There is finally some cause for optimism, after decades of reports and recommendations.
The most recent is the report of the Expert Advisory Group on a pan-Canadian Health Data Strategy, which was comprised of diverse experts from across Canada and the health sector. The keystone of the report is the recommendation for a Health Data Charter that can serve as a unifying vision around which all health sector stakeholders, including governments, First Nations Inuit and Metis, health care providers and the public, can frame a common approach to health data design and use.
Crystalized in 10 concise points, the Health Data Charter starts with the premise that health data should be “person-centric,” with the collective obligation to maximize the health
and wellbeing of individuals and populations. While sounding simple, truly person-centric health would dramatically alter Canada’s health data by transforming the current architecture from being largely provider-centric, which too often fragments individuals’ health data between family doctors, hospitals, labs, pharmacies, private clinics, nursing homes and so on.
The foundational importance of health data to the quality and sustainability of Canada’s health care sector is clear. Optimizing Canada’s health data will require a strong harmonized approach centred on the welfare of individual Canadians.
Following the First Ministers meeting, the various bilateral agreements should all include a common pan-Canadian commitment to cooperation across jurisdictions and specific resourcing for advancing health data transformation. The Health Data Charter provides a clear framework upon which to build such cooperation. n H







MAY 28-30 AT THE BEANFIELD CENTRE, TORONTO

e-Health is the premier event for Canadian digital health professionals working to make a difference in health and healthcare delivery. Since its inception in 2000, the e-Health Conference and Tradeshow has served as a vital epicentre of Canadian digital health discussion and debate, attracting upwards of 1,000 health professionals annually.
e-Health is the optimal spot for networking and knowledge-sharing with peers nationally and around the globe.






Hundreds of health professionals from across Canada will convene at e-Health – in the beautiful LEED-certified, open floor-plan Beanfield Centre – to enjoy all the benefits of in-person networking during breakfast and lunch, over coffee at regularly scheduled breaks, and at social events sched-


uled throughout the week. Attendees can walk the trade show floor to interact with more than 75 leading-edge healthcare, technology, and consulting organizations, and visit the innovative newcomers in the StartUp Zone. e-Health 2023 Conference and Tradeshow takes place May 28-30 at the Beanfield Centre, Toronto.
With in-demand speakers, expert panelists and presenters, and leading-edge exhibitors, e-Health always delivers memorable education and networking opportunities. The e-Health 2023 program is packed with opportunities for learning with over 179 sessions scheduled over two days. Read the following program highlights for a sample of the learning and networking opportunities available at e-Health. Visit e-healthconference. com to see the complete program. n H
 By Don Sweete
By Don Sweete
In 2007, Apple launched the iPhone, a piece of technology that would revolutionize the world and put the power of a supercomputer in consumers’ pockets. That same year, represented by Canada Health Infoway, Canada, along with eight other countries, became a founding charter Member of SNOMED International. SNOMED International is the non-profit organization that maintains and evolves SNOMED CT, the world’s most comprehensive computable language of health, setting the commendable goal of creating the “one language of health” and driving improved patient outcomes worldwide.
clinicians, researchers, governmental bodies and other stakeholders with unlimited access to and use of the terminology. Some Members have mandated its use; England, for example, now requires its use in the country’s electronic patient record systems. The terminology is also widely used in non-Member countries through affiliate licensing agreements.
SNOMED CT is a clinical terminology that allows for the consistent representation of clinical content in electronic health records (EHRs). With more than 350,000 concepts, it is considered both the gold standard for clinical terminology and a key enabler of interoperability.
or in different locations. Even nonSNOMED CT users can quickly find out what a SNOMED CT code represents using the organization’s newly developed SNOMED CT concept lookup tool.
Since those early days, a total of 47 countries in the Americas, Europe, the Middle East and the Asia-Pacific, and one regional government in Africa, have joined the organization. Interest in the benefits SNOMED CT enables continues to grow, and every year more countries are taking steps to offer those benefits to their citizens, whether as part of their national digital health strategies, institutional research goals or efforts to improve local healthcare provision. Once a Member, countries can provide their nations’
The SNOMED CT International Edition is constantly being refined and revised monthly through formal and informal collaboration with other health standards bodies and professional organizations. In Canada, Infoway produces the country’s national extension, which contains content specific to Canadian clinical use cases, and released every March and September.
Generally, interoperability in healthcare refers to timely and secure access to health information so that health data can be used to positively impact health outcomes for patients, citizens and the communities they live in. Achieving this is increasingly important as more health systems adopt EHRs and more populations around the world age and experience multiple
chronic conditions requiring care from a vast constellation of providers.
The challenge, however, is that approximately 80 per cent of health data is unstructured and can represent text, photos, X-rays, voice/video recordings, slides and emails and other types of data. Moving along its maturity model, this unstructured data can first be coded using SNOMED CT, which then enables the use of data analytics, population health management and other secondary uses of EHR data.
The adoption of SNOMED CT facilitates interoperability with SNOMED CT-enabled clinical information systems, health data and analytics platforms and interoperability solutions. These digital tools, when enabled with SNOMED CT, introduce a new standard for structuring patient and citizen clinical data. The users of SNOMED CT-coded data, including other providers, can be assured they are speaking the same language, making it easier and safer for patients receiving care from different providers
A founding Member of SNOMED International, Canada recently announced it will provide $505 million over five years to Canada Health Infoway, the Canadian Institute for Health Information and federal data partners to work with provinces and territories to develop new health data indicators, support the creation of a Centre of Excellence on health worker data, advance digital health tools and an interoperability roadmap, and underpin efforts to use data to improve safety and quality of care.
Owing to Canada’s existing federal investments, Infoway notes that the use of SNOMED CT in various digital health projects in Canada has enabled the sharing of diagnostic images and reports anywhere and at any time in the provinceofOntario.Canadianscanalso carry vaccination records on personal mobile devices and receive automated vaccination reminders via consumer applications such as CAN Immunize Interoperability has long been identified as one of the most critical pieces to enabling seamless patient care. Canada’s early and enthusiastic participation in this initiative and Infoway’s work to advance awareness and adoption of SNOMED CT have resulted in significant achievements that we expect to yield ever greater benefits for Canadians over the coming years. Interested in connecting with us at eHealth 2023? We’ll be at Booth 77. You can also email us at info@ snomed.org. n H
SNOMED CT IS A CLINICAL TERMINOLOGY THAT ALLOWS FOR THE CONSISTENT REPRESENTATION OF CLINICAL CONTENT IN ELECTRONIC HEALTH RECORDS (EHRS).
SUNDAY, MAY 28
3:30 pm-4:30 pm
4:30 pm-5:30 pm
President’s Reception
5:30 pm-7:30 pm
Welcome Reception
MONDAY, MAY 29
8:30 am-10:00 am – Opening
Ceremonies and Keynote
The Role of Digital and Technology on Our Future Workforce: Reinvention to build a futureready healthcare workforce (This presentation is sponsored by Accenture)
The gap between supply and demand for care is growing too fast, and health systems must find a solution – today. Caregivers are burned out and leaving the workforce. In the United States alone, nearly 500,000 nurses (17 per cent of today’s total workforce)
are expected to leave the profession in the next five years. Hiring more caregivers won’t solve the problem for the long term. The only solution is to reinvent the nature of care delivery. It’s time to learn from other industries that are scaling human labor with technology. It’s not about technology replacing people, it’s about technology augmenting the work of people to lessen the burden on the healthcare workforce and help enable better outcomes. We will explore how a combination of human + machine can help increase efficiency for physicians, nurses and the nonclinical workforce so that they may meet the rising demand for care. Adopting such a model allows the organization to use technology to automate and optimize work, improves interoperability to reduce silos and increase speed, and helps build agile teams that can work in connected environments. Ultimately, technology must give
SPONSORED CONTENT
time back to humans to support productivity and redistribution of effort. Technology will never replace physicians, but we can increase their capacity through technology. Clinical care and operations can be better supported by an environment that automates tasks, accelerates insight and gives human decisionmakers superpowers through AI. Reinventing care drives efficiency, but it also enables healthcare workers to have greater wellbeing and better work experiences that leave them happier, healthier and more productive. Accenture’s “Care to do Better” research across multiple industries in 10 countries showed that satisfying human needs in the workplace unlocks
Kaveh Safavi

workers’ full potential – and that has a significant positive impact on the business. Attendees will learn:
• What technologies health systems need to adopt to achieve a human + machine model, including artificial intelligence which can perform non-routine tasks to scale workforce and enable patients to serve themselves.
• What oppor tunities metaverse technologies present to allow create greater access, better experiences and improved outcomes while keeping people at the heart of healthcare.
• The importance of Accenture’s “Net Better Off” framework, which quantifies human wellbeing across six dimensions.
Zebra offers the industry’s broadest portfolio of healthcare-grade hardware and software solutions that integrate effortlessly across operations.
Patient identification solutions enhance safety, reduce errors and elevate quality of care. With our powerful, purpose-built mobile computers clinicians accomplish more in less time. Our specialty printers are so reliable

and easy to use that you’ll almost forget about them. And our tracking solutions keep you continuously aware of the real-time location and status of critical resources, equipment and much more.
With Zebra solutions you give your team more control and more power to work efficiently, so they can take back their day and gain more time for care.
To learn more about Zebra technologies visit Zebra.com/Healthcare n H
Kaveh Safavi, M.D., J.D., is a senior managing director at Accenture where he is responsible for leading, developing and driving a growth strategy that differentiates Accenture’s offerings for providers, health insurers, and public and private health systems across the globe. A seasoned executive, Dr. Safavi brings more than three decades of leadership experience to Accenture Health. Prior to joining Accenture in 2011, Dr. Safavi led Cisco’s global healthcare practice. Before that he was chief medical officer of Thomson Reuters’ health business, vice president of medical affairs at United Healthcare, and had leadership roles at HealthSpring and Humana. Among his many accomplishments was establishing one of the Midwest’s first electronichealth-record-enabled primary care practices. Dr. Safavi has published numerous papers and is often quoted on healthcare issues in various media publications, including The Wall Street Journal, the BBC, The New York Times, Consumer Reports, US News and World Report, Harvard Business Review and The Economist. Recently, IT Services Report named him the #1 healthcare IT executive
for 2020. Dr. Safavi earned an M.D. from Loyola University School of Medicine and a J.D. from DePaul University College of Law. He is board-certified in internal medicine and pediatrics and completed his medical residency at the University of Michigan Medical Center. An adjunct lecturer of Health Enterprise Management at Kellogg School of ManagementNorthwestern University, Dr. Safavi also serves on the Weinberg College of Arts and Sciences’ Board of Visitors–Northwestern University and is a frequent guest scholar at the Stanford University Clinical Excellence Research Center. He is a member of the Easterseals National Board of Directors.
Unburden the delivery of care for your clinicians by leveraging easy, holistic and interoperable technology solutions from just one partner — ZebraKaveh Safavi
March 28-30 | Toronto
March 28-30 | Toronto
Visit Zebra at Booth #42
Visit Zebra at Booth #42
Purpose-Built for Healthcare Mobility
for Healthcare Mobility
Empower healthcare workers with dependable mobile computing solutions
Empower healthcare workers with dependable mobile computing solutions



Give every patient the highest quality care with Zebra’s TC52ax-HC Mobile Computers and ET4x-HC Tablet.
Give every patient the highest quality care with Zebra’s TC52ax-HC Mobile Computers and ET4x-HC Tablet.

TC52ax-HC Mobile Computers
TC52ax-HC Mobile Computers
Wi-Fi™ 6 support
Wi-Fi™ 6 support
Increased memory for maximum application performance
Increased memory for maximum application performance
Healthcare-grade materials
Healthcare-grade materials
ET4x-HC Tablet
ET4x-HC Tablet
5G and Wi-Fi 6 connectivity
5G and Wi-Fi 6 connectivity
Built-in scanner and emergency alert button
Built-in scanner and emergency alert button
Disinfectant-ready housing
Disinfectant-ready housing
Zebra
ZEBRA and the stylized Zebra head are trademarks of Zebra Technologies Corp., registered in many jurisdictions worldwide. Wi-Fi™ is a trademark of Wi-Fi Alliance®. All other trademarks are the property of their respective owners. ©2023 Technologies Corp. and/or its affiliates. 03/22/2023 ZEBRA and the stylized Zebra head are trademarks of Zebra Technologies Corp., registered in many jurisdictions worldwide. Wi-Fi™ is a trademark of Wi-Fi Alliance®. All other trademarks are the property of their respective owners. ©2023 Zebra Technologies Corp. and/or its affiliates. 03/22/2023(continued)
10:30-11:30
– Concurrent Sessions






Pod 1
10:30-10:45 – Developing a Balanced Scorecard of Quality Indicators in Virtual Care (Oral)
10:45-11:00 – Virtual Urgent Care after COVID – What have we learned? (Oral)
11:00-11:15 – Transforming Care with Access to Virtual Interpreters (Oral)
11:15-11:30 – Virtual Care @ Library (Oral)
Pod 2
10:45-11:00 – A novel pediatric virtual care evaluation framework, and its evolution (Oral)

11:15-11:30 – Impact of remote care on patient and provider experience (Oral)
Pod 3
10:30-10:45 – Enhancing equitable access to care through appropriate virtual care use (Oral)
10:45-11:00 – Patient/Provider Satisfaction with an EHR-Integrated Video Appointment Solution (Oral)

11:00-11:15 – Virtual Harm Reduction Services- a Provincial Overview from BC (Oral)

11:15-11:30 – HomeGIM: How virtual models of care facilitated early discharge in the pandemic (Oral)
Pod 4
10:30-10:37 – Virtual nursing stations – saving the hospital health workforce (Rapid Fire)
10:40-10:47 – Effective Scaling of Virtual Care Strategies (Rapid Fire)
10:50-10:57 – Enabling prehospital Virtual Health – Paramedic Video Clinical Consultation (Rapid Fire)
Accenture is a global professional services company with leading capabilities in digital, cloud and security. Combining unmatched experience and specialized skills across more than 40 industries, we offer Strategy and Consulting, Technology and Operations services and Accenture Song – all powered by the world’s largest network of Advanced Technology and Intelligent Operations centers. Our 699,000 people deliver on the promise of technology and human ingenuity every day, serving clients in more than 120 countries. We embrace the power of change to create value and shared success for our clients, people, shareholders, partners and communities. Visit us at accenture. com. Accenture Health harnesses the power of technology and human ingenuity to help clients improve access, experience, and outcomes in healthcare. With the help of our innovative, technology-enabled services, clients are delivering effective and personalized experiences that humanize healthcare for all. For more information, visit https://www.accenture.com/ca-en/industries/health-index
11:00-11:15 – Case Studies of Health Equity and Virtual Primary Care (Oral)
11:15-11:30 – Feasibility of implementing telemonitoring for high-risk pregnant women in Pakistan (Oral)


Pod 5
10:30-10:45 – Assessing Virtual Care Maturity to inform Strategic Priorities (Oral)
10:45-11:00 – Using Virtual Care to Support Patients Living with Liver Disease (Oral)
11:00-11:15 – Evaluating stakeholder relationships in virtual care learning health system implementation (Oral)
11:15-11:30 – Alternative Virtual Care solutions in Ontario First Nations communities (Oral)
Pod 6
10:30-11:00 – Hospital at Home: Patient-Centered Care Through Innovation and Technology (Panel)
11:00-11:15 – Developing a system-wide telestroke network –international insights for Canada (Oral)





11:15-11:30 – Virtual care use prior to emergency department admissions in Ontario (Oral)
Pod 7
10:30-11:00 – Developing Culturally Appropriate PedsICU Virtual Healthcare in Rural/Remote Indigenous Communities (Panel)
11:00-11:15 – Reduction on Emergency Department Demand By Healthlink Virtual MD Program (Oral)
11:15-11:30 – Co-design with patients to improve experiences of virtual patient education (Oral)
Pod 8
10:30-11:00 – Health System Transformation using Evidencebased Digital Health Innovation (Panel)
11:00-11:15 – Nurse-led Integrated Care of Complex Patients Facilitated by Telemonitoring (Oral)
11:15-11:30 – Utilizing Rpm to Support Clients at End of Life (Oral)
7:30 am-10:00 – e-Health



Social Night with live music and refreshment – celebrating the return to in-person networking!
8:30-9:30 – Plenary Panel –Embracing the possibilities in ML/AI innovation
(This presentation is sponsored by Novartis).
Machine learning and artificial intelligence (ML/AI) along with augmented reality are shaping and disrupting health systems across the globe. In this exciting plenary session, we will be talking to industry leaders at the forefront of this new era to share their real-world experience with implementing ML/AI in the healthcare setting, debunk the myths about smart technology, and bring a pragmatic lens on how governments and healthcare organizations can embrace this innovation in a safe, trusted, and sustainable manner.
The problems with service access and patient transitions have been well documented in Canada. These problems could involve the public, unaware of where to turn for help at critical moments in their life. It could be clinicians, confused about which community health service could help their patient. Solving these problems is capturing the attention of local health leaders coming together, using modern health care technologies.
Ontario, for example, has 54 newly formed Ontario Health Teams (OHTs) that have assembled groups of providers and organizations. These entities are becoming accountable for delivering a full and coordinated continuum of care to their defined geographic populations. Each of these newly formed partnerships have prioritized smoother transitions to community services, with a common focus on seniors with chronic illness and individuals with mental health concerns. The lasting effects of the COVID-19 pandemic have made it crucial to expedite improvement timelines. Here’s how OHTs and other organizations are leveraging Caredove today:
In order for organizations with different services, IT systems, and processes to collaborate, their

respective systems must be able to communicate. Caredove can integrate eReferral data with any application using Ontario’s HL7 FHIR eReferral specification, which has become the standard across Canada. Caredove was the lead contributor in the development of this specification, and we continue to expand our integrations.
Many organizations are looking beyond only providing service navigation by also providing online appointment booking to help clients connect to the right person at the right organization to receive timely care. Caredove is building secure, cross agency, booking portals on many network websites like Great River OHT and Community Connect YYC.


Mental Health Service Access
Improving public connection to mental health and addictions
services through programs like AccessMHA and Counselling Connect.
Innovating Community Healthcare
Expanded access to community paramedicine programs like communityparamedics.ca are helping individuals with chronic health conditions live independently at home while reducing hospital readmissions and lowering healthcare costs.
6 Provinces
Caredove has been tested and proven by over 800 organizations across Ontario, and has helped connect over 1 million people with the right person at the right community service.

Access is complicated. It doesn’t need to be. How Caredove is enabling smoother transitions to community services today.
and works with EY’s regional and local health teams to drive value for clients in the market. Her technical areas of focus include strategic planning, performance improvement, and smart health technology innovation. She holds an MBA from the Thunderbird School of Global Management, a BA in Psychology from the University of California at Berkeley and is PMP and LSS GB certified.
Rachel
Aloha brings over 25 years of consulting experience and works with both private and public sector health and wellness entities around the globe. She leads EY’s Global Health sector, defines EY’s global health solutions


Rachel is an AI Council member for the UK government and Visiting Professor at Imperial College London, UK, Co-chair of OpenEHR CiC and Chief Industry Advisor of the global health software company Dedalus. She has over 25 years’ experience in the UK National Health Service (NHS), academia, management consulting, and the technology industry. Rachel was previously Chief Executive Officer of the NHS Dig-
For over 25 years, CPDN has provided simple, consolidated, direct, and economical distribution to Canadian Hospitals. Our members and customers leverage our consolidated distribution model and comprehensive technology services to operate with greater efficiency and transparency, leading to reduced operational costs and back-office time. If you have questions, please contact us at info@cpdn.ca
ital Academy, leading postgraduate education programs both nationally and internationally, and the National Care Alliance Director of Digital and Group Chief Information Officer at the Royal Salford NHS Hospital in Greater Manchester, UK, where she implemented data science and AI approaches to health and wellbeing. Recently she led the KLAS Research Arch Collaborative initiative for electronic health record optimization and supported the ‘Big 4’, consulting in Australia, New Zealand, USA, Europe, and low–middle income countries. Rachel is also Health Lead for the UK government’s artificial intelligence roadmap and contributed to policy including the UK AI strategy.
June 1, 2022, where he is responsible for country operations and leadership across the entire organization.
Prior to this, Mr. Marazzi held the position of Country Pharma Organization Head, Novartis pharmaceuticals, Canada, Inc. where he let the Canadian Pharma Organization through his transformation journey with compelling vision and strategy; set the talent and culture agenda to create an environment conducive to innovation and smart risk-taking for bigger impact; ensured fast and broad access to innovation (8 NME approved in 18 months, including 2 gene therapies); and worked to strengthen the healthcare system through partnerships and high-tech innovation to improve patient comes.
Before coming to Canada, Mr. Marazzi held the role of Chief Commercial Officer, Europe, based in Novartis’ headquarters in Basel, Switzerland. He was responsible for the strategy and execution of the full portfolio across all European countries, and the five pharmaceutical therapeutic areas, with specific focus on commercial excellence, operationalization of new launches and in-market brands, as well as capability and talent development. In his capacity of CCO, Mr. Marazzi, led the creation of the European Rare Disease organization and succeeded in transforming the business model to be more focused on improving the patient journey and accelerating the time to access for treatments.

With over 20 years of deep pharmaceutical leadership experience across the globe, Andrea Marazzi was appointed Country President, Novartis Pharmaceuticals Canada Inc. on
Mr. Marazzi join Novartis in 2001 and held multiple positions of increasing responsibility over the years in Sales and Marketing, Customer Solutions, Brand Strategy, Finance and Strategic Planning in several therapeutic areas and indifferent geographies. His professional aspiration is to drive transformational improvement of healthcare systems, and patient outcomes across the globe, and he is passionate about the role that technology and strategic public-private partnership can play to achieve this mission.
Mr. Marazzi has a Degree in Economics with Honours from the University of Bocconi in Milan, completed several Harvard Finance programs
and has a Post Graduate Certificate in Leadership from the University of Glasgow Caledonian.























Dr. Bradly Wouters
Bradly is an internationally recognized leader and cancer researcher. He became Executive Vice President of Science and Research at UHN in 2016 and prior to that served as the Interim Director of Research at the Princess Margaret Cancer Centre since 2014. He joined UHN in 2008 as Senior Scientist and Director of the Princess Margaret Hypoxia Program,
and has held faculty appointments at the University of Toronto in the Department of Medical Biophysics and the Department of Radiation Oncology since that time. Prior to joining UHN, Dr. Wouters was Professor and Head of Experimental Radiation Oncology at Maastricht University in the Netherlands. As EVP of Science and Research, Dr. Wouters is focused on creating an environment that incentivizes, facilitates, and rewards excellence in basic, translational, and clinical research across all elements of UHN.

(continued)
4:00 – 5:00 p.m. Closing
Keynote with Dr. James Makokis
(This presentation is sponsored by Novartis).

Dr. James Makokis leads one of North America’s most progressive family medical clinics serving both LGBTQ2S and First Nation peoples from all over Canada. Dr. James Makokis is a national and internationally recognized leader and author in the area of Indigenous health and transgender health. Recently named to “The Medical Post’s 2021 Power List,” Dr. Makokis believes that power should be shared, especially with those who have been disempowered. His philosophy of leadership is based on Nehiyô iyintiw wiyasiwewina (Cree Natural Laws) including kisewatisiwin (kindness), kwayask itatisiwin (honesty), sohkeyitamowin

(strength/determination), and pahkwenamatowin (sharing) as taught to him by his Elders.
He is a proud Cree, Two-Spirit physician from Saddle Lake First Nation in Northern, AB and known as one of Canada’s most progressive doc-

tors and experts on numerous topics. Through his work, he is on a mission to serve marginalized populations and to change the outcomes for Indigenous and LGBTQ2S Peoples. Dr. James Makokis and his partner Anthony Johnson were crowned winners of the Amazing Race Canada Season 7, where they received international recognition for their advocacy of marginalized individuals by making the world aware of the impact of discrimination and the mistreatment of anyone labelled as being “different”. They both currently reside on Treaty 6 Territory outside of Edmonton.
He faced many challenges earlier on in establishing his career as an Indigenous doctor. Being Two-Spirit, from a small segregated and poverty-stricken community, forced him to prove himself, try to ignore hurtful statements against him, and develop coping strategies to manage systematic and social forms of discrimination. His success as a doctor is in large part his downto-earth approach with his patients, as he can easily empathize with them and the challenges they face before providing his medical advice. He was also mentored by many Canadian and Indigenous leaders along his path, which gave him unique insights into a wide variety of issues that people face around the world and in Canada. Dr. James Makokis has travelled alongside former Governor General Michaëlle Jean on a diplomatic mission to Brazil and also had the rare opportunity to
work next to Dr. Patch Adams in the Amazon Jungle.
He has received international attention and recognition for his holistic approach to medicine and his advocacy for human rights. He is also one of the few doctors that combine traditional Cree medicine and Western medicine within his practice. Known for his compassion, numerous accomplishments and his unique insights, Dr. James Makokis has inspired all types of Canadians to challenge stereotypical and often discriminating views towards First Nation and LGBTQ2S Peoples. He has won numerous awards, sat on many boards and councils, and continues to give back to his communities in any way he can. Through his work and his previous contributions, he continues to break down stigmas and identify the societal structures and forces of oppression that LGBTQ2S and Indigenous populations face.
Dr. James Makokis wanted to be a doctor since he was four years old. It was during his education that he decided to focus on LGBTQ2S and Indigenous health so that he could make a difference for those often left out of the healthcare system and society as a whole. The attitudes and discrimination individuals he serves face within the health care system and in their personal lives, often leads to his patients being marginalized and underserved through the imbalance of trust, access and service for their health. He is here and on a mission to create real change
by serving marginalized populations and rebuilding relationships with those who have are often left behind.
He earned his Master’s in health science from the University of Toronto in 2006 and graduated from the University of Toronto’s medical school in 2010 and the University of British Columbia’s Aboriginal Family Medicine Residency Training Program in 2012. He is also trained in family medicine and trans health. He is dedicated











to continuing to save lives through his medical practice and his unique approach to medicine. Dr. Makokis worked as an instructor at the Yellowhead Tribal College, the University of Toronto, and the University of Alberta, teaching courses on Indigenous health, Indigenous cultural practices, and traditional medicine. He also received certification from the Aboriginal Family Medicine Training Program and served as the Spokesperson for the
Novartis is reimagining medicine to improve and extend people’s lives. We deliver high-value medicines that alleviate society’s greatest disease burdens through technology leadership in R&D and novel access approaches. The Novartis BIOME is a catalyst for impactful digital collaboration and unites the best of science and technology to create better healthcare solutions and patient experiences at scale. The BIOME reinforces Novartis’s commitment to partner with the entire health ecosystem to jointly innovate and co-develop digital solutions.
National Aboriginal Health Organiza tion’s Role Model Program for many years.


He shares a wide range of his per sonal experiences, areas of expertise, Indigenous knowledge and his com passionate understandings with audiences for his quest to serve others and bring measurable change within the nation. Dr. James Makokis feels a calling to share the struggles and challenges of individuals and communities that are often left behind.
As a speaker, Dr. Makokis shares his family history, Indigenous history, real-life examples from his patients, and his personal experience within his presentations. His focus is to help us all celebrate each person’s uniqueness while showing us all how to improve ourselves so that we can be in the best position to positively impact others, for the larger contribution of the human experience. n H




Join us for a thought-provoking discussion on: Transforming the Patient Experience and Improving Access to High-Quality Care


Monday, May 29 | 1PM – 2PM | Pod 1
Then stop by our booth to discover our portfolio of digital health solutions. www.calian.com/health



Celebrate being back in person again! Come out for in-person socializing at the e-Health social night (sponsored by Accenture) on Monday, May 29 from 7:30–10:00 PM. Live band, food stations, drink tickets (+ paid bar), dancing, fun, and networking. Location: Beanfield Centre plenary floor.




or healthcare organizations, staying at the forefront of technological advances can be challenging and expensive. But being up to date on the latest healthcare innovations is essential for ensuring positive outcomes for patients and a better work experience for care providers.
Innovative developments in recent years, many of them driven by the constraints of the pandemic, have transformed the care experience for both patients and care teams. From virtual healthcare applications to automation and artificial intelligence (AI), healthcare technology is opening new possibilities for more personalized, efficient, cost-effective care. Healthcare organizations that embrace these technologies are setting themselves up for success as well as positioning their organizations for future growth.
Calian continues to lead the way helping care providers to offer the cutting-edge virtual care their patients have come to expect. Corolar Virtual Care can be integrated with existing electronic health records (EHR) and scheduling systems for a seamless patient and clinician experience. Features such as secure messaging and the ability to book appointments online provide the convenience and speed that are becoming ubiquitous – and expected – in modern healthcare.
Artificial Intelligence and automation are becoming increasingly common in the modern healthcare setting, as AI systems can help identify patterns and generate insights to expedite processes and reduce errors. This is especially beneficial for accuracy-sensitive treatments, such as drug dosage calculations, imaging post-processing, real-time screening in hospital settings and population health analytics.
Automation delivers better efficiency, allowing healthcare professionals to focus their attention on more challenging cases that require more specialized attention. As many of these technologies become more scalable, more patients are expected to benefit from significantly improved quality of care with reduced staff needs and financial costs.
Wearable technologies have huge potential for healthcare monitoring and diagnostics. Using sophisticated sensors and miniaturized components, these devices enable care providers to track and assess a patient’s vital signs in real time. These technologies have the potential to detect hidden health issues and detect them earlier, potentially saving lives. Remote health monitoring can reduce patient re-admission rates and support our aging population – all with fewer health care providers. This lowers the cost of care, while maximizing patient benefits.
Having access to this valuable health data gives care providers the tools to manage chronic conditions more effectively or quickly identify
warning signs of more serious issues. With an increasing number of products being developed and refined every day, wearable technologies that can be monitored remotely are transforming the way we manage health and diagnose illness.
The data collected from health monitoring apps and virtual care platforms can play an important role in improving clinical results. Through data analytics, care providers can visualize trends, identify gaps in care pathways and apply predictive models. This allows physicians to make more informed decisions when treating a patient and helps ensure that individuals are receiving the best care possible. Data analytics can also highlight areas in the overall care journey that need improvement and drive accountability for health institutions.
When choosing a healthcare platform, there are several key attributes to consider.
• Security and privacy to protect patient data and ensure confidentiality. The platform should comply with
relevant regulations such as HIPAA and GDPR.
• Ease of use for both patients and healthcare providers. It should not require extensive training or technical expertise.
• Accessibility from a variety of devices and internet connections. The platform should be compatible with mobile devices, laptops and desktop computers.
• Flexibility and integration adaptability with other healthcare systems such EHR, scheduling applications and billing systems.
• Customizability to meet the needs of different healthcare organizations adapting to different clinical workflows and care pathways.
• Cost-effectiveness to help ensure that healthcare organizations can continue to provide high-quality care while managing costs.
While healthcare technologies are becoming widely available to patients, there are still challenges that can limit their widespread use: cost and complexity, lack of user training and support, and concerns around data privacy and cybersecurity.

Despite these obstacles, it is undeniable that the future of healthcare is predicated on innovative digital health solutions – and with the incredible leaps taken over the past several years already, it’s just a matter of time before we see even greater advancements being made in this space.
Do you want to learn more about how your organization can provide faster, cost-effective and better care for patients?
Stop by the Calian booth at eHealth to discover an innovative portfolio of healthcare solutions. Attend the sponsor symposia on May 29th from 1-2pm for panel discussions on healthcare innovation, followed by a Q&A and solution demonstrations. n H





If I had to choose, I would say I am most looking forward to spending time meeting and talking to hundreds of stakeholders walking the open-plan tradeshow floor, enjoying a coffee with Digital Health Canada members at breaks, and exchanging ideas at networking events. After two years of great virtual events that filled the knowledge-sharing gap, I am really looking forward to the serendipity of randomly running into someone and sparking a great five-minute meeting.
I am also looking forward to the pan-Canadian content that will be offered in the concurrent sessions – 179 of them – focused on timely topics and issues including advances in connected and personalized care, novel applications of artificial intelligence, innovation in digital mental health, patient engagement technologies, and more. And, hearing from professionals from across Canada as they share their experiences implement-
ing change and transforming care delivery from a system, provider, and patient perspective.
There’s simply no better way to stay current and sharpen your knowledge and skills than by exchanging information and ideas with peers from across the country. As a conference host, I have the privilege of an advanced look at the attendees who’ve already registered, the conference program, as well as the full list of innovative sponsor and exhibitor organizations lining up to partner with us in presenting #eHealth2023. From what I’ve seen, it is going to be an exceptional experience.
Come prepared to network and build your career as a professional, to learn from digital health professionals from across the country, and to help grow your organization as a key stakeholder in the field of digital health in Canada.



See you in Toronto May 28-30! n H
Mark Casselman CEO, Digital Health Canada
What
I most
















GetReady® is a digital patient management solution that enables hospitals and clinics to remotely manage their patients and provide personalized procedure preparation, follow-up care, and monitoring — including risk monitoring for waitlisted patients — from the comfort of the patient’s home.
Learn more at medtronic.ca/GetReady
From ChatGPT to robust machine-learning algorithms, artificial intelligence (AI) is already having an unquestionable impact on society and the world of scientific research. But how do we combine these advancements with human expertise and the wishes of patients and families when it comes to health care?
Dr. Melissa McCradden, a Bioethicist with the Bioethics Department and Associate Scientist in the Genetics & Genome Biology program, and Dr. Roxanne Kirsch, a Clinical Associate in the Bioethics Department and Staff Physician in the Cardiac Critical Care Unit, are experienced in systematically exploring ethical issues in health care. McCradden is also the John and Melinda Thompson Director of Artificial Intelligence in Medicine for Kids (AIM), a program that seeks to support SickKids innovators in developing and integrating AI into care delivery.
In a recent article published in Nature Medicine, these two researchers explore whether AI really does “know best” and where it can fit in the provision of medical care, including common and confusing misconceptions about the role of AI in health care.
To unravel some of these thoughts a little further, we asked McCradden and Kirsch to discuss some of the key points behind the article.
– Dr. Melissa McCradden“Humans have always loved technology, and although adoption has been slower in the health-care sector compared with the private sector, there is still evidence of hyperbolic claims and misunderstandings surrounding the role and nature of AI. Wording in media can be quite strong – for example, suggesting doctors can be replaced – and it gives a problematic impression of technology’s role and function,” explains McCradden, who
is leading the bioethical framework development that governs ethical AI model integration at SickKids in her role at AIM.
“These misrepresentations and the resulting impressions can complicate the dynamic between the doctor and the patient and family. By being clear about what each brings to the table and what AI will likely do in the future of care – support doctors, rather than replace – we can retain the best of both AI and human decision-making.”
– Dr. Roxanne Kirsch“By approaching each patient encounter with an awareness of the imbalance, it allows the clinician to then provide space for patient and family viewpoints,” explains Kirsch, who is also the Associate Chief, Equity, Di-
versity, Inclusion, Wellness and Faculty Development for Perioperative Services.
“For example, physicians can help ensure clear and informed consent around a treatment plan by explaining their thinking behind a recommendation they’re providing to a family, including the role that AI prediction played in the decision-making. That way, patients and families are not only aware of the extent to which AI may be impacting their care, there’s room carved out to talk about it with their doctor.”
Awareness of the power imbalance is key to mitigating that imbalance.
“AI’s unique benefit is its ability to compute many different and additional sources of information much faster than any other technology we’ve had
before. However, like many of the test results and various inputs that are taken into consideration now, clinical decision-making still requires the clinician to interpret and consider those inputs in the context of the individual patient they are caring for,” says Kirsch. “Both Dr. McCradden and I advocate for clinicians to continue to centre shared decision-making and inclusive practices, with AI forming a part of the medical evidence that clinicians draw from to provide medical recommendations.
McCradden adds: “We anticipate AI will provide an additional stream of high-quality information to support decision-making by the clinician. These sources of information should then be integrated with the patient values, goals and preferences to reach a decision about how to proceed with that person’s individual care plan.”
Want to learn more? Read the full article, “Patient wisdom should be incorporated into health AI to avoid algorithmic paternalism. n H
More than 100,000 Canadians are living with Parkinson’s and most only see their doctor once or twice a year. This means that for every one hour of care, a person has 8,765 hours of self-management annually.
But finding resources for this complex disease can be daunting. Digital health solutions have potential to support people in their self-management of Parkinson’s during the in-between moments around medical care.
In 2022, Parkinson Canada put out a call for research proposals to fund a digital health app, that will empower people with Parkinson’s to optimize their health. This funding opportunity provided a research team with up to $300 000 over three years. Proposals were reviewed by a group of scientific experts, as well as people
with Parkinson’s from the Parkinson Advisory Council.
The funding from this competition was awarded to Dr. Tiago Mestre, a Movement Disorder Specialist, and his team at The Ottawa Hospital who are developing a digital health tool called eCARE-PD. The eCARE-PD app aims to support Parkinson’s selfcare as well as connecting people to community supports. App users can monitor symptoms and aspects of daily activity, like exercise and sleep, to help them set healthcare goals and recognize trends in their disease. The app also includes educational content on different topics related to Parkinson’s.
“eCARE-PD provides a sense of empowerment that can help [a person] know more about their Parkinson’s and what to expect and better deal with it”, says Mestre.
Parkinson Canada is thrilled to support the development of the eCARE-PD app and to work alongside the research team at The Ottawa Hospital to share this tool with Canadians with Parkinson’s when it becomes available in the future.
“Contributing funding and supporting the broader roll-out of eCARE-PD in the community aligns with Parkinson Canada’s aims to impact more people throughout their journey with Parkinson’s, and ensure people have access to the right technology to support their efforts to live well with Parkinson’s,” says Angelica Asis, Vice President Research.
Learn more here. For more information about Parkinson Canada, please visit Parkinson.ca or join the conversation on Facebook, Twitter and Instagram. n H
New digital health app will address the unique needs of Canadians living with Parkinson’s
Like most of us, Tim and Jennifer Robinson thought birthmarks were a discolouration on a baby’s skin that often faded with time.
But the first-time parents got a lesson on lesser-known types when their son Oliver was born with a birthmark on his neck that was a balloon-like growth rather than a stain.
Birthmarks, called vascular anomalies in the medical field, are growths made up of blood vessels that have developed incorrectly. These growths may be solid or made up of arteries, veins, capillaries, lymph vessels, or any combination of these.
One in 10 children has some kind of vascular anomaly, says Dr. John Donnellan, head of pediatric imaging and pediatric interventional radiology at Hamilton Health Sciences’ McMaster Children’s Hospital (MCH), and site chief. In almost all cases, these children are born with their birthmarks, but they can become more obvious as they age. Most are minor and do not require treatment.
Vascular anomalies are divided into two categories – tumors and malformations. Tumors are the discolourations that often fade with time and can be monitored by a family doctor.
Malformations have three types –lymphatic, venous and arterial. These birthmarks are best treated with interventional radiology.
Interventional radiologists use their expertise to guide tiny instruments, such as catheters, through blood vessels or through the skin to treat a wide variety of medical conditions that in the past would have required surgery.
“Through minimally-complicated procedures, we can make huge changes in children’s lives,” says Donnellan. “It’s incredibly rewarding to help these children and their families.”
Oliver, now 18 months old, received two treatments as an infant for the lymphatic malformation on his neck. Treatments are done on an outpatient basis, meaning kids can go home afterwards and don’t need to stay overnight in hospital. While Oliver’s growth couldn’t be completely
removed, it was shrunk to the point where it’s barely visible.
“It’s a birthmark, so it’s not something that can be cured,” says Donnellan.
“But I can certainly make this kind of birthmark smaller by shrinking it down to the size where no one other than the child or parent would notice it. I’ve treated a couple of newborns where the birthmark on their neck was bigger than their head, and can usually get those down to being flat and almost completely gone.”
Interventional radiologists use ultrasounds, x-rays and sometimes CT scans to guide minimally-invasive surgical procedures, including treating certain types of birthmarks.
Oliver’s lymphatic malformation was discovered during a prenatal scan when Jennifer was 32 weeks pregnant. The growth measured 10 cm, and she was referred to MCH for additional tests. “It was very frightening at the time,” recalls Jennifer.
Further testing showed that the growth wasn’t blocking the baby’s airway, or posing any other danger. The couple was assured that it could be treated, and after Oliver’s birth they were referred to MCH’s Pediatric Vascular Anomalies Clinic where they met with Donnellan to discuss treatment options.
Interventional radiology is the fastest, easiest and most effective treatment, says Donnellan. “Surgery is no longer recommended as a first-line option because once the growth is removed, lymph-producing cysts may form on the scar, making it too wet to ever heal properly. Surgery can actually make the child’s quality of life worse, and then there’s very little we can do about it.”
A lymphatic malformation is essentially a cyst, or sac of skin filled with lymph fluid. It occurs when lymph vessels form abnormally, and are most common on the head and neck.
They’re not life threatening and won’t turn into cancer, but they can be uncomfortable and attract negative attention. In some cases, they can also affect mobility if not treated. Oliver’s growth was so large, it forced his head to one side and would have made movements like rolling over next to impossible.
With most malformations, the growth’s size corresponds to the body’s size. So if it represents one per cent of the body at birth, it will remain one per cent for the rest of the person’s life if not treated.
“But as children grow, the birthmark doesn’t necessarily grow in the same direction,” says Donnellan. “As a child grows taller, their birthmark may become more prominent by growing wider. Some birthmarks even swell and shrink repeatedly.”
Donnellan treats these birthmarks with a procedure called sclerotherapy, which is best known for treating varicose and spider veins. A needle is used to remove the fluid from the sac, and then a solution is injected into the sac that causes its lining to stick together so the sac can no longer fill with fluid.
After just two treatments, Oliver’s bump is now almond-sized and only noticeable to his parents. It’s expected to shrink even more with time, though it will never disappear completely.

During Oliver’s first treatment, when he was one month old, Donnellan drained 600 ml of fluid from the sac which weighed more than a pound.
“Oliver weighed 10.5 lbs before the procedure and 9.2 lbs after,” says Jennifer. The second treatment, a few weeks later, removed the remaining fluid.
Oliver now has some loose skin around his neck from the empty sac, but it will tighten as he grows. Down the road, if needed, he can have surgery to further tighten any remaining loose skin.
Arterial malformations: This type is the most difficult, by far, to treat. They happen when an abnormal tan-
Oliver was born with a large birthmark on the side of his neck. Thanks to treatment at the Pediatric Vascular Anomalies Clinic at McMaster Children’s Hospital, it’s now barely visible.
gle of blood vessels, usually connecting arteries and veins, disrupts blood flow and oxygen circulation. Treating them involves inserting tiny metal coils or glue via a small catheter into the birthmark to block it off and cause clotting.
“With this treatment, I’m usually trying to prevent the child from reaching an amputation too early,” says Donnellan. “But unfortunately, arterial malformations almost ultimately end in amputation due to pain and skin breakdown from the growing vessels. For example, if this birthmark was on a fingertip, that section of the finger may need to be amputated.”
Donnellan hopes to raise awareness of the Pediatric Vascular Anomalies Clinic among parents as well as family doctors.
“A lot of family doctors aren’t aware we have this clinic. We want the medical community and the community-at-large to know that interventional radiology can do a great deal to help these young patients.” n H
Asimple vitamin could successfully treat a rare but potentially fatal genetic disease, according to new research led by a Concordia undergraduate student. In a paper published in the Journal of Inherited Metabolic Disease, the authors describe how vitamin B5 can mitigate the life-altering and life-threatening effects related to mutations in the Transport and Golgi Organization 2 (TANGO2) gene in Drosophila melanogaster – fruit flies. Flies with the mutation exhibited symptoms commonly associated with TANGO2 deficiency disease (TDD): they died of starvation almost twice as fast as those without it, had difficulties moving and learning and had a neuromuscular defect that manifested as spasms when exposed to high temperatures. However, when flies with the mutation were supplemented with vitamin B5, these symptoms quickly improved or, in some cases, disappeared.
“TDD is a very rare disease, but some clinicians noticed that phenotypes in patients with TDD resembled phenotypes in individuals who can’t metabolize lipids very well,” says Michael Sacher, a professor from the Department of Biology in the Faculty of Arts and Science and the paper’s supervising author. Lipids are fatty compounds that perform several important functions, including moving and storing energy and producing hormones. They are generally activated by bonding with the coenzyme A molecule, which needs vitamin B5 to be produced.
“Since TDD is a lipid metabolism problem, we thought that if we just boosted production of coenzyme A, we would see some sort of effect on the fruit flies,” Sacher continues. “And that was exactly the case.”
The paper’s lead author is Paria Asadi, who expects to complete her BSc in
fall 2023. She designed and conducted a series of assays to record the differences between control and experimental groups of fruit flies. Asadi first studied the behaviour of fruit flies with the mutation and noticed phenotypes consistent with TDD seen in humans: they died 50 per cent faster if deprived of food, suggesting a metabolic defect; they exhibited ataxia, a neurodegenerative condition characterized by poor muscle control and abnormal movements, among other symptoms; they exhibited intellectual deficits during in a learning assay, in which the flies were slower to avoid exposure to the bitter taste of quinine than those without; and they were more susceptible to seizures when exposed to higher temperatures. She then repeated these experiments on another line of fruit flies with the TDD mutation but with vitamin B5 added to their food. The results were not only remarkable – they were also quick. “We saw that
they had improved, in some cases to wild levels,” she says. “They did not have a very significant learning deficit or metabolic crises after starving. This shows that vitamin B5 can potentially be therapeutic for TDD patients.” Other types of B vitamins were also used in tests, but none led to rescues as pronounced as B5.
The researchers noticed degrees of improvement even after a very short exposure to vitamin B5. The longer the exposure, however, the more marked those improvements were. “We were seeing a time-dependent rescue,” Sacher says. “Presumably, that would hold for humans as well. Even if a neurodevelopmental delay has occurred, which unfortunately happens to children, we can at least try to prevent a potentially fatal metabolic crisis.” Asadi recalls presenting these
Paria Asadi: “Just knowing how meaningful the research we are doing is for the lives of TANGO2 deficiency disease–affected families was a turning point in my life.”
findings at a TDD family conference in summer 2022 where she had a chance to talk to families affected by the disease. “One of the mothers told me that since her child started taking multivitamins their lives had changed for the better. Just knowing how meaningful the research we are doing is for the lives of affected families was a turning point in my life,” she shares. “It made me realize how biological research at the molecular level can be impactful for so many people.” n H
Concordia researchers Miroslav Milev and Djenann Saint-Dic and former Concordian Chiara Gamberi, now at Coastal Carolina University in the United States, co-authored the paper. The study was supported by the Canadian Institutes of Health Research, the Natural Sciences and Engineering Research Council of Canada (NSERC), the TANGO2 Research Foundation, the National Institute of Health and the IDeA Network for Biomedical Research Excellence.



Shannon Reid is helping to continue bringing patient-centred care to the forefront of Toronto Rehab’s Specialized Dementia Unit (SDU).
An Advanced Practice Leader for the SDU, Shannon became a certified coach in 2021 to lead a practical dementia education program for staff. She now leads Gentle Persuasive Approaches (GPA) training on the SDU, and other programs across Toronto Rehab’s University Centre, to provide staff with the knowledge, skills and confidence they need to deliver exceptional patient care.
“Dementia changes how a person experiences the world,” says Shannon. “It impacts many different things, such
as memory and judgement, which can result in the responsive behaviours we see on the SDU, including pacing, restlessness, repetitive questions and physical aggression.”
The ultimate goal of GPA training, which is designed for all frontline interdisciplinary team members, is to understand each person with dementia as a unique human being.
“The curriculum includes gentle physical redirection techniques our staff can apply, to help deter patients
from unsafe situations or altercations,” says Shannon.
These techniques include gentle physical techniques to remove a patient from an unsafe situation such as an altercation with a co-patient, and self-protective techniques for staff to use if they are being grabbed, kicked or pinched by a patient.
The evidence-based course focuses on promoting personhood, explaining the different damages to the brain caused by dementia and
identifying strategies that can be used to support patients. It emphasizes that there is meaning behind each behavioural response, and that these responses are the result of an unmet need.
“It’s an extremely practical course that offers real strategies my team and I can use on a daily basis,” says Shannon.
‘Helps us gain a better understanding of a person outside of their diagnosis’

The learning is comprehensive and accessible for staff with different learning styles, and is comprised of videos, auditory learning components and hands-on activities, such as small group learning and role playing.

Home care is about trust. It is feeling comfortable with a provider coming into the home of someone you care for and, possibly, assisting with the most intimate care.


Bayshore’s home care services are extensive, varied, and personalized for each individual. Whether it’s just a little assistance for daily tasks or round-the-clock care, Bayshore’s caregivers can help your loved ones to live their best life while remaining at home.
1.877.289.3997
bayshore.ca
“A PATIENT MAY BE VERY UPSET AND TEARFUL, AND SOMETIMES PROVIDING VALIDATION AND REASSURANCE IS ALL THEY NEED.”
Mary-Anne Garcia, a recreation therapist at Toronto Rehab’s SDU, says the GPA course has improved the way she builds trust and rapport with patients

“GPA teaches you that personhood-promoting interactions not only help in the moment, but also help patients living with dementia feel safe with you,” says Mary-Anne.

“A patient may be very upset and tearful, and sometimes providing validation and reassurance is all they need. The way we interact and communicate with them is key, whether that’s validating their emotions, actively listening or spending one-on-one one time with them.”
Toronto Rehab plans to have an additional Advanced Practice Lead certified to provide GPA training, as the course is expanded to other programs within the hospital, to ensure

patient needs are aligned with staff expertise.
“The training is beneficial for all staff because it helps us gain a better understanding of a person
Photo: UHN

outside of their diagnosis,” says Mary-Anne.
“It allows everyone to work collaboratively as a team and ensure we are on the same page when providing quality care.” n H
transition
patients,


Provide VHA'sLeadHomeCareAgencyModelisanintegrated modelofcarewhichprovides: tosupportpatientstoreceivespectacularcareintheir ownhomesandcommunity.


Opioid overdose crisis is a growing public health concern in Canada that was exacerbated by the COVID-19 pandemic. Most of this crisis was related to opioid use disorder (OUD), a chronic condition that is commonly associated with personal, social, and public health consequences. OUD may involve prescribed medications and street drugs. To reduce opioid-related harm (e.g., risk of opioid overdose), OUD can be effectively managed by opioid agonist therapy (OAT), in combination with psychosocial and behavioural therapy and supports. OAT often requires extensive assessment, monitoring, and follow-up where the patient would benefit from a multi-disciplinary healthcare team to fulfill these roles.
In 2018, the Canadian Medical Association Journal (CMAJ) published a National Clinical Practice Guideline on the Management of Opioid Use Disorders, in which OAT with buprenorphine-naloxone is the recommended first-line treatment option for OUD. Patients who can be retained in OAT longer are likely associated with a reduction of drug use and better quality of life.
Buprenorphine, a long-acting partial opioid agonist, can relieve opioid withdrawal symptoms and cravings for at least 24 hours when administered sublingually. It has a lower risk of overdose and respiratory depression when compared to other full opioid agonists (e.g., methadone). The addition of naloxone to buprenorphine does not affect patient retention in OAT; the buprenorphine-naloxone combination has shown to be more effective than abstinence-based therapy, offers a better side-effect and drug-interaction profile, and a more flexible model

of care, in particular, for patients with prescription related OUD. Readers can refer to the 2017 Canadian Family Physician journal article on “Primary Care Management of Opioid Use Disorders” to learn more about recommended treatment options for different patient populations. The flexibility offered by buprenorphine-naloxone will also benefit patients with improved accessibility to OAT and reduced potential harm with respect to opioid overdose.
Despite the COVID-19 pandemic, pharmacists continue to be the most accessible healthcare provider and therefore can be leveraged to increase access to OAT and help tackle the opioid crisis. OAT access can be extended to all care settings where pharmacists are involved, for instance, community practice, inpatient and outpatient settings, and transitions of care. Pharmacists are uniquely positioned where they can provide the full pharmaceutical care work-up, which includes, but not limited to, comprehensive medication
therapy management, OAT assessment/selection, patient education, monitoring (of withdrawal symptoms and potential non-adherence or drug-diversion concerns), and follow-up (with appropriate dose adjustments accordingly, etc.). Included in the work-up is also ensuring that there are no drug-drug interactions and if there are, it would be included in the monitoring parameters. In the community, pharmacists can improve patient retention in OAT post-discharge by helping patients through coordination of appointments with their providers or ensuring their prescription refills not running out.
Buprenorphine-naloxone is available in multiple fixed-ratio strengths (e.g., 2 mg/0.5 mg; 8 mg/2 mg). Healthcare providers often refer only to the strength of the buprenorphine component of the buprenorphine-naloxone combination (i.e., “8” rather than “8 mg/2 mg”). In 2019, the Institute for Safe Medication Practices Canada (ISMP Canada) published a Safety Bulletin where a mix-up be-
tween two types of OAT (i.e., methadone and buprenorphine-naloxone) occurred due to a lack of standardized documentation or incomplete documentation in the medication administration record at the pharmacy. Some of the lessons learned from this incident included the significance of independent double checks in pharmacy practice and the use of standardized documentation templates for OAT in all pharmacies and clinics within the province or territory.
Below is a list of other resources pertaining to safe medication use of OAT:
• Centre for Addiction and Mental Health (CAMH). Opioid Agonist Therapy: A Synthesis of Canadian Guidelines for Treating Opioid Use Disorder. Published May 2021. Available from: https://www.camh. ca/-/media/files/professionals/canadian-opioid-use-disorder-guideline2021-pdf.pdf
• Bruneau J, Ahamad K, Goyer MÈ, et al. Management of opioid use disorders: a national clinical practice guideline. CMAJ 2018;190(9):E247-E257.
• Canadian Research Initiative on Substance Misuse (CRISM). CRISM National Guideline for the Clinical Management of Opioid Use Disorder. Published 2018. Available from: https://crism.ca/wp-content/ uploads/2018/03/CRISM_NationalGuideline_OUD-ENG.pdf
• Srivastava A, Kahan M, Nader M. Primary care management of opioid use disorders: Abstinence, methadone, or buprenorphine-naloxone? Can Fam Physician 2017 Mar;63(3):200-205.
• Institute for Safe Medication Practices Canada (ISMP Canada). Lack of Standardized Documentation Contributes to a Mix-up between Methadone and Buprenorphine-Naloxone. ISMP Canada Safety Bulletin 2019;4:1-6. n H






When 25-year-old RN Michaela Parenteau paused her work with Pikangikum First Nation to volunteer with Canadian Medical Assistance Teams (CMAT) in Ukraine, she didn’t know what to expect. Being stationed along the Ukraine-Poland border in a shipping container that was transformed into a fully operational primary care clinic, Parenteau saw more than just medical crises.

As many Ukrainian women and children fled to Poland, while men stayed in Ukraine to fight for their country, Parenteau witnessed devastating goodbyes and history repeating itself. “It was like those old black and white pictures of people in the trains, and they’re all waving to their partners with their hands out the window…There were double-decker buses of families and it’s all women and children passing by to the border with blank stares, and you know they’ve been through chaos and heartbreak. It’s the same image but in colour,” she explains.
The unpredictable nature of the war did not stop Parenteau from making the journey and bringing her knowledge and expertise as a nurse directly to the frontlines. She applied for the deployment as soon as RNAO’s callout email arrived in her inbox. As an Indigenous nurse from Wabigoon Lake Ojibway Nation in northwestern Ontario, she felt compelled to go. “I don’t have Ukrainian roots but I felt that what was happening in Ukraine –the displacement of people, the cultural genocide, families being separated – is similar to Canada’s colonial past. I wanted to be on the right side of history and use my health-care background to help in any way needed.”
In its nearly 15 years as a grassroots emergency response organization that provides medical aid in major global disasters, this was CMAT’s first conflict-based deployment. Over the course of three months (March – June 2022), CMAT deployed eight teams to Poland and Ukraine to provide surge capacity, as millions of Ukrainians fled to Poland seeking refuge. Despite some bureaucratic challenges, CMAT
CMAT shares a tweet on June 3, 2022 about its partnership with RNAO featuring an image with the official CMAT badge in the middle of RNAO’s RN and NP pins.

signed a contract with Polish Medical Mission and established its presence in shipping containers along the border, as well as mobile clinics to care for internally displaced people in Ukraine. With the help of RNAO and its internal planning committee to recruit RNAO members, CMAT received more than 400 applications in the first week from motivated nurses willing and eager to volunteer their time and expertise to the deployment.
During her 17-day deployment (May 16 – June 3) on CMAT’s Team Foxtrot – comprised of one NP, four other RNs, two physicians, two interpreters and a logistics lead – Parenteau provided physical, mental and emotional support to anyone who needed it. She heard many stories of anguish, trauma and devastation, but says it was rewarding to just be there to listen. “I’ve never been hugged by patients as much as when I was in Ukraine,” she shares, emphasizing that it was also necessary to administer frequent psychosocial care.
RN Kerri Tadeu was also part of Team Foxtrot and says her background in psychiatry was heavily uti-
Above: Beginning in early March 2022, RNAO partnered with Canadian Medical Assistance Teams (CMAT) to deploy volunteer RNs and NPs to Poland and Ukraine to provide care to people displaced by the war.
lized throughout the deployment, despite the language barriers. She recalls meeting a Ukrainian soldier with signs of post-traumatic stress disorder who desperately wanted to return to fight for his country but needed treatment. While the NP on her team, Shereen Worrad, spoke privately with the soldier’s wife, Tadeu looked him in his eyes to establish a therapeutic relationship and tried her best to communicate with him via Google Translate to reassure him that he was in a safe space. “He ended up giving me a box of matches with the Ukrainian flag and I gave him Canadian flag pins,” shares Tadeu. “It might not seem like a lot, but the compassionate and non-judgmental care he received from us helped him agree to get the actual care he needed, which was hospitalization.” Moments like these have formed what Tadeu calls her “core memories” during her time in Ukraine.
Another core memory, shared by both Tadeu and Parenteau, was frequently being asked in disbelief by refugees and residents of Poland in near-
by villages, “You came from Canada to help us?” It was apparent that nurses’ willingness to provide person-centred care showed no boundaries, and people were grateful for CMAT’s presence and support amid the conflict.
Because Team Alpha provided a solid foundation in March 2022, all of the other teams – Bravo, Charlie, Delta, Echo, Golf and Hotel – were able to provide compassionate and unified care in a short amount of time.

When the war began on Feb. 24, 2022 RN and MPP for Mississauga Centre Natalia Kusendova knew she had to do something to help, especially given her Polish background. “For a few weeks I was talking almost every day with my relatives in Poland and was thinking of what I can do to help out in not only my role as MPP, but also as a nurse.”
RNAO CEO Dr. Doris Grinspun connected Kusendova with CMAT, and Kusendova joined what she calls “pre-Team Alpha” to help organize the deployment and navigate the bureaucratic and administrative hurdles. “I actually had a meeting at the Polish
Ministry of Health, so using my MPP connections and my heritage, I was able to help establish that first medical deployment at the border crossing,” says Kusendova. But her RN status also played an important role when meeting with different levels of government in Poland, as well as local authorities, such as firefighters and paramedics, to determine the most effective way for CMAT to work with the local teams. “When I spoke to the minister of health in Poland, being able to say ‘I am a licensed professional in Ontario, Canada and I am a member of RNAO’ gave me a certain level of credibility when we talked about things like providing medical aid at the border,” adds Kusendova.
Now back home, Kusendova reflects on her involvement with CMAT and the important role of nurses, especially during global crises. “For us as nurses, you never know where life and your nursing expertise will lead you… especially living in a country like Canada. To bring Canada to other countries was something I was really proud of when I went to the border, and people saw the Canadian maple leaf and really recognized that as a symbol and a beacon of democracy.”
Although deploying to an active war zone overseas posed numerous safety risks, many of the nurses who volunteered with CMAT say they did not feel unsafe because there were clear safety measures and protocols in the event they received an air-raid siren

alert on their mobile devices, for example. In fact, NP Corsita Garraway, who also deployed to Ukraine with Team Alpha, says entering a danger zone is something nurses are used to and her safety wasn’t something she considered before she left. Instead, when people would ask Garraway about volunteering in a warzone, she would explain: “that’s what nurses do – we go to danger zones. We’re the ones working in emergency – it’s what’s we do, we look after people. Look at COVID-19 for example, that’s a danger zone, but nurses get the call and we go.”
This was Garraway’s first time volunteering as a nurse, although it was always something she was interested in doing. She says she loved being in Poland to help people in the ways she knew how as an NP, providing relief for both physical and emotional pain.

The experience in Poland had a lasting impact on Garraway to the extent that when she returned to Canada, she accepted a contract position in a long-term care home in Newfoundland. Garraway credits her time with CMAT for pushing her to go and says, “If I can go to Poland, I can definitely be in Canada and go to a place where there is a crisis in nursing… That experience actually invigorated me.”

Just like Garraway, Team Alpha member, RN Ameek Singh, shares that he was also revitalized by the journey and inspired to expand his skillset since returning home from deployment. He is in the process of transitioning from a stroke rehabilitation program to mental health emergency. In Poland, Singh says Team Alpha saw all types of medical needs and would triage the clinical situation based on each team member’s expertise. Given it was often a one-time visit with patients, he strived to always make a positive impact, but was mindful of his own limitations when providing care related to mental health. “There’s no point to retraumatize a person to talk about the challenges they’re facing, if I don’t have the solution for them,” explains Singh. “Part of the reason why I’m expanding my scope of work is to be a better trauma-informed clinician, so if I do go back (to Poland or Ukraine), I bring not only my skillset as an emergency nurse but also a mental health nurse that can navigate those challenging waters.”
When asked if he’d go back, Singh responds without hesitation “in a heartbeat.” And he’s not alone. Although being deployed a few months after Singh and having faced differ-

ent circumstances, Parenteau also would’ve stayed to help if that was an option and says her team shared that mentality given their seamless teamwork and positive impact on the people they served. “Everybody was there to help,” she says, and adds that “it’s all volunteers, so (helping) is just their passion. I feel like it’s more than a team. It’s a family doing great work.”
The nurses who travelled with CMAT during this deployment offered up their knowledge and expertise in an unfamiliar place during a difficult time, and in return they truly made a difference helping those in dire need. They also gained memories and important lessons to inform their practice back home. Nurses can lend their expertise and lead change in a number of impactful ways throughout their careers, which is why Singh encourages all nurses to embrace different opportunities and expand their knowledge to ultimately provide better care and improve health outcomes.
“Reach out to people outside of your comfort zone… Explore your unknowns so we can understand each other better,” says Singh. To learn more about its volunteer opportunities or to donate, please visit CMAT.ca. n H



This year, we celebrate Lab Week April 9-15
At Roche, we’re thankful to all professionals who work in diagnostics and laboratory services. We invite everyone to thank a laboratory hero for all the work they do and all the patients that they impact.

Let’s celebrate Lab week and raise awareness of the role medical laboratory professionals play in Canada’s healthcare system.
Always a Hero. Celebrate and honor laboratory professionals